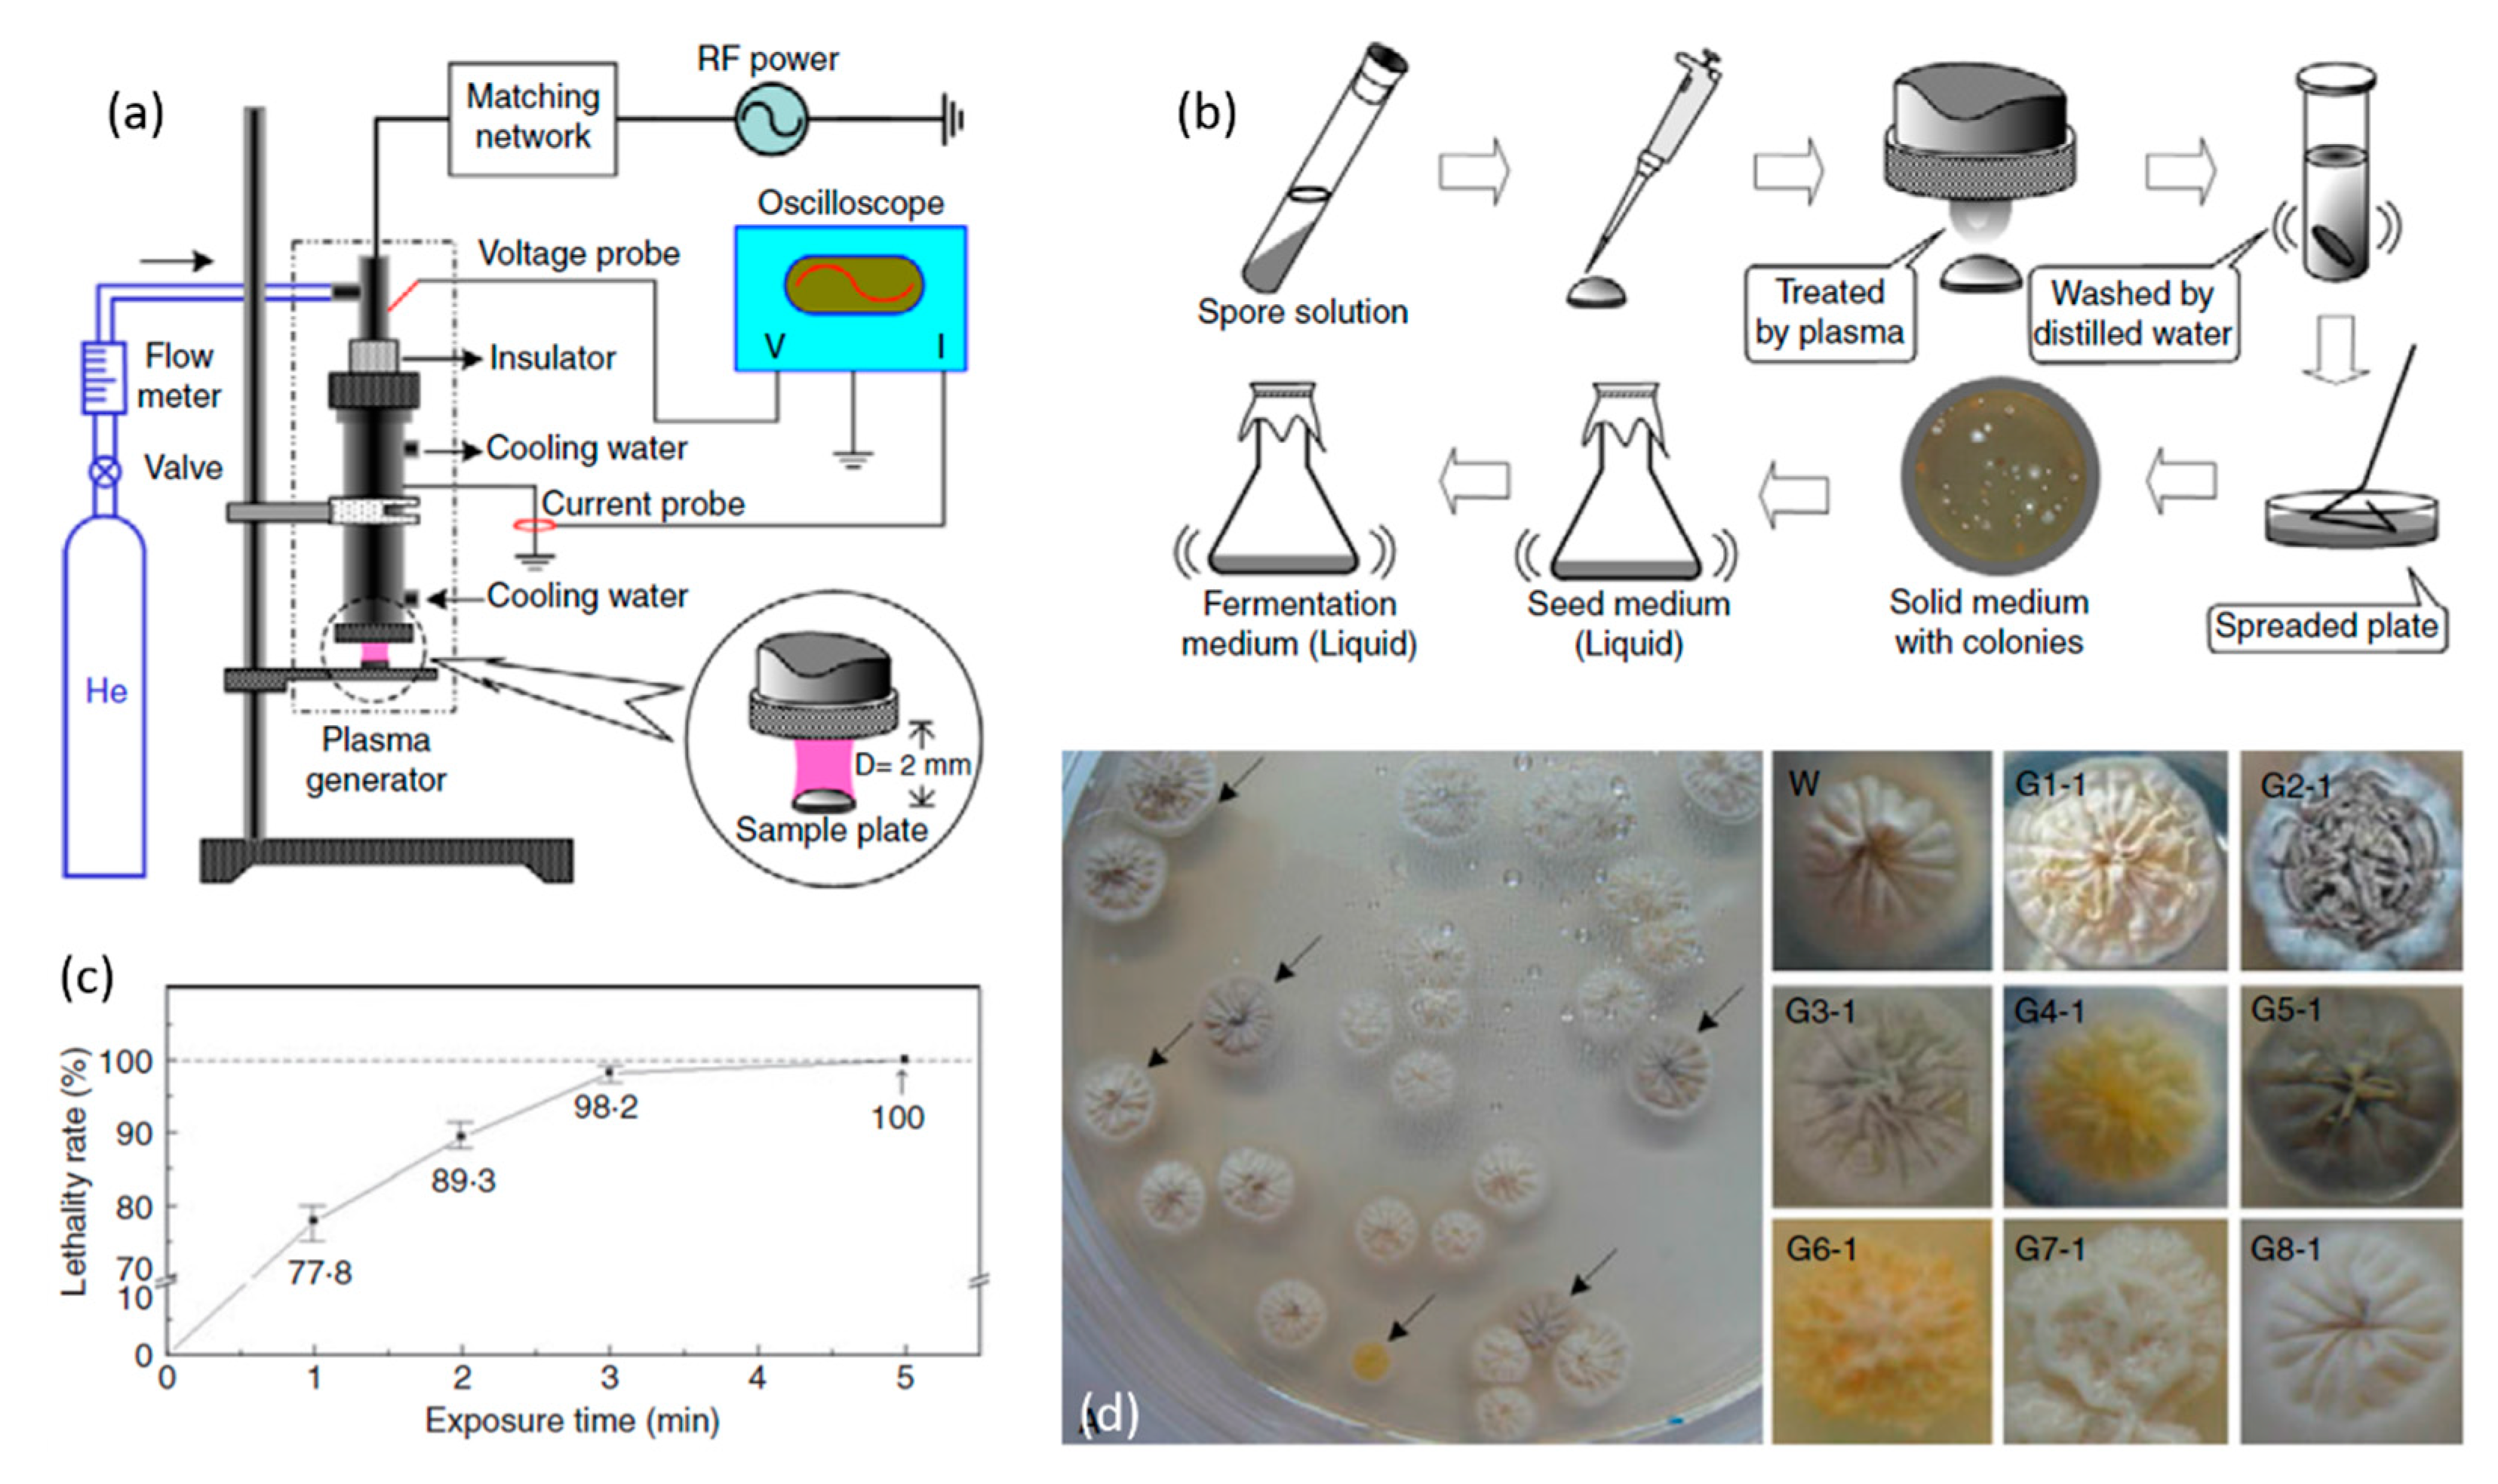
Materials 12 02751 g016 Materials 12 02751 g016

Applications of Plasma-Liquid Systems: A Review
Abstract
1. Introduction
2. Plasma
3. Applications of Plasma-Liquid Systems
3.1. Plasma in Nanomaterial Processing
- In both the liquid-cathode and liquid-anode cases, the secondary electrons can dissolve into the liquid to form hydrated electrons (eaq−), which are very strong reducing species in the NP synthesis process [56]. Moreover, other plasma species including atomic hydrogen, H2, H2O2 (with different reducing abilities depending on the pH value) and hydride (H−) (very strong reducing species) are also able to reduce metal ions in the solutions in both cases. However, it has been reported that the yield of these reducing species in the liquid-anode case is much less than the yield in the liquid-cathode case. During PLIs, some oxidizing species can also be generated including atomic oxygen, ozone and OH• radicals [56].
- The pH of the plasma-treated liquid plays an important role in the NP synthesis process. For example, the reduction ability of H2O2 is stronger in basic media than in acidic ones [56].
- “Plasma in liquid” systems show a relatively higher reducing efficiency compared to the “plasma over liquid” systems [56].
- Sputtering and evaporation are two physical processes frequently used for nanomaterial synthesis in plasma-liquid systems [56].
- It was shown that the type of metal ions strongly affects the synthesis process and also strongly affects the quality of the resultant NPs. For example, under similar plasma conditions, Au NPs were observed at both plasma cathode and anode, while Ag NPs were only found at the plasma cathode [56].
3.2. Plasma in Analytical Chemistry
3.3. Organic Wastewater Treatment
3.4. Plasma Sterilization and Disinfection
3.5. Plasma Biomedicine, Wound Healing and Blood Coagulation, Plasma Dermatology and Dentistry
3.6. Plasma Oncology and Cancer Therapy
3.7. Plasma Agriculture and Food Safety
3.8. Plasma in Dielectric Media
3.9. Plasma in Polymeric Media
4. Conclusions and Perspective
Author Contributions
Funding
Conflicts of Interest
Abbreviations
| AC | Alternating current |
| CHL | Chloroform |
| DBD | Dielectric barrier discharge |
| DC | Direct current |
| DCM | Dichloromethane |
| DMA | N,N-Dimethylaniline |
| DMF | N,N-Dimethylformamide |
| DPBS | Dulbecco’s phosphate buffered saline |
| EEM | Excitation-emission matrix |
| ELCAD | Electrolyte-cathode discharge |
| EPR | Electron paramagnetic resonance |
| FE-DBD | Floating electrode dielectric barrier discharge |
| FGF | Fibroblast growth factor |
| GC-MS | Gas chromatography-mass spectroscopy |
| GDE | Glow discharge electrolysis |
| HBSS | Hank’s balanced salt solution |
| ICCD | Intensified charge-coupled device |
| ICP | Inductively coupled plasma |
| IMDM | Iscove’s modified Dulbecco’s medium |
| LIBS | Laser-induced breakdown spectroscopy |
| LTE | Local thermodynamic equilibrium |
| MALDI | Matrix-assisted laser desorption ionization |
| MW | Microwave |
| NAC | N-acetylcysteine |
| NMR | Nuclear magnetic resonance |
| NP | Nanoparticle |
| NPP | Nano-pulsed plasma |
| OES | Optical emission spectroscopy |
| PAN | Polyacrylonitrile |
| PAW | Plasma-activated water |
| PBS | Phosphate buffered saline |
| PCL | Poly-ε-caprolactone |
| PEO | Polyethylene oxide |
| PEPT | Pre-electrospinning plasma treatment |
| PLA | Poly lactic acid |
| PLIs | Plasma-liquid interactions |
| PLLA | Poly-L-lactic acid |
| PVP | Polyvinyl pyrrolidone |
| RF | Radiofrequency |
| RNS | Reactive nitrogen species |
| RONS | Reactive oxygen and nitrogen species |
| ROS | Reactive oxygen species |
| RPMI | Roswell Park Memorial Institute |
| SCCM | Standard cubic centimeter per minute |
| SEM | Scanning electron microscopy |
| SFM | Serum-free medium |
| SPB | Sørensen’s phosphate buffer |
| TCE | Trichloroethylene |
| UHT | Ultrahigh temperature |
| UV | Ultraviolet |
| XPS | X-ray photoelectron spectroscopy |
References
- Trasatti, S. Water electrolysis: Who first? J. Electroanal. Chem. 1999, 476, 90–91. [Google Scholar] [CrossRef]
- Gubkin, A. Reduced matrix interferences compared to flames. J. Ann. Phys. Chem. 1887, 32, 114–115. [Google Scholar] [CrossRef]
- Janek, J.; Rohnke, M.; Pölleth, M.; Meiss, S.A. Plasma Electrochemistry with Ionic Liquids. In Electrodeposition from Ionic Liquids; Wiley Online Library: Hoboken, NJ, USA, 2008; pp. 259–285. [Google Scholar]
- Langmuir, I. Oscillations in ionized gases. Proc. Natl. Acad. Sci. USA 1928, 14, 627–637. [Google Scholar] [CrossRef] [PubMed]
- Wuthrich, R.; Ziki, J. Micromachining using Electrochemical Discharge Phenomenon: Fundamentals and Application of Spark Assisted Chemical Engraving; William Adrew: Norwich, NY, USA, 2014. [Google Scholar]
- Hickling, A.; Ingram, M. Glow-discharge electrolysis. J. Electroanal. Chem. 1964, 8, 65–81. [Google Scholar] [CrossRef]
- Hickling, A.; Ingram, M. Contact glow-discharge electrolysis. Trans. Faraday Soc. 1964, 60, 783–793. [Google Scholar] [CrossRef]
- Glasstone, S.; Hickling, A. Studies in electrolytic oxidation. Part V. The formation of hydrogen peroxide by electrolysis with a glow-discharge anode. J. Chem. Soc. 1934, 390, 1772–1773. [Google Scholar] [CrossRef]
- Hickling, A. Electrochemical processes in glow discharge at the gas-solution interface. Mod. Asp. Electrochem. 1971, 6, 329–373. [Google Scholar]
- Klemenc, A.; Ofner, G. Neue Wege in der Anwendung elektrischer Energie auf chemische Vorgänge Glimmlichtelektrolyse. Berichte Bunsenges. Phys. Chem. 1953, 57, 615–617. [Google Scholar]
- Klemenc, A.; Kohl, W. Glimmlichtelektrolyse. XXV. Mon. Chem. Verwandte Teile And. Wiss. 1953, 84, 498–511. [Google Scholar] [CrossRef]
- Couch, D.; Brenner, A. Glow discharge spectra of copper and indium above aqueous solutions. J. Electrochem. Soc. 1959, 106, 628–629. [Google Scholar] [CrossRef]
- Brenner, A.; Sligh, J. Electrodeless Electrolysis. J. Electrochem. Soc. 1970, 117, 602–608. [Google Scholar] [CrossRef]
- Klüpfel, K. Untersuchung des Überganges elektrischer Ströme zwischen Flüssigkeiten und Gasen. Ann. Phys. 1905, 321, 574–583. [Google Scholar] [CrossRef]
- Makowetsky, A. The formation of hydrogen peroxide, nitric acid and ammonia in the glow discharge with water as one electrode. Z Elektrochem. 1911, 17, 217–235. [Google Scholar]
- Harada, K. Amino acid synthesis by glow discharge electrolysis: A possible route for prebiotic synthesis of amino acids. In The Origin of Life and Evolutionary Biochemistry; Springer: Boston, MA, USA, 1974; pp. 183–205. [Google Scholar]
- Harada, K.; Iwasaki, T. Syntheses of amino acids from aliphatic carboxylic acid by glow discharge electrolysis. Nature 1974, 250, 426–428. [Google Scholar] [CrossRef] [PubMed]
- Harada, K.; Iwasaki, T. Syntheses of amino acids from aliphatic amines by contact glow discharge electrolysis. Chem. Lett. 1975, 4, 185–188. [Google Scholar] [CrossRef]
- Harada, K.; Suzuki, S. Formation of amino acids from elemental carbon by contact glow discharge electrolysis. Nature 1977, 266, 275–276. [Google Scholar] [CrossRef] [PubMed]
- Kareem, T.; Kaliani, A. Glow discharge plasma electrolysis for nanoparticles synthesis. Ionics (Kiel) 2012, 18, 315–327. [Google Scholar] [CrossRef]
- Miller, S.L. A production of amino acids under possible primitive earth conditions. Science (80-) 1953, 117, 528–529. [Google Scholar] [CrossRef]
- Komelkov, V.S. Mechanisms of dielectric breakdown of liquids. Dokl. Akad. Nauk. SSSR 1945, 47, 268–270. [Google Scholar]
- Skvortsov, N.M.; Komelkov, Y.V.; Kuznetsov, V.S. Expansion of a spark channel in a liquid. Sov. Phys.-Tech. Phys. 1961, 5, 1100–1112. [Google Scholar]
- Kuzhekin, I.P. Investigation of Breakdown by Rectangular Voltage Pulses of a Liquid in an Inhomogenous. Field. Sov. Phys. Tech. Phys. USSR 1967, 11, 1585. [Google Scholar]
- Sharbaugh, A.H.; Devins, J.C.; Rzad, N.E. Progress in the Field of Electric Breakdown in Dielectric Liquids. IEEE Trans. Electr. Insul. 1978, 13, 249–276. [Google Scholar] [CrossRef]
- Devins, J.; Rzad, S.; Schwabe, R. Breakdown and prebreakdown phenomena in liquids. J. Appl. Phys. 1981, 52, 4531–4545. [Google Scholar] [CrossRef]
- Singh, B.; Chadband, W.G.; Smith, C.W.; Calderwood, J.H. Prebreakdown processes in electrically stressed insulating liquids. J. Phys. D Appl. Phys. 1972, 5, 1457. [Google Scholar] [CrossRef]
- McKenny, P.; McGrath, P. Anomalous positive point prebreakdown behavior in dielectric liquids. IEEE Trans. Electr. Insul. 1984, 2, 93–100. [Google Scholar] [CrossRef]
- Forster, E. Research in the dynamics of electrical breakdown in liquid dielectrics. Electr. Insul. IEEE Trans. 1980, 3, 182–185. [Google Scholar] [CrossRef]
- Allan, R.; Hizal, E. Prebreakdown phenomena in transformer oil subjected to nonuniform fields. Electr. Eng. Proc. IEEE. 1974, 121, 227–231. [Google Scholar] [CrossRef]
- Wong, P.; Forster, E. High-speed schlieren studies of electrical breakdown in liquid hydrocarbons. Can. J. Chem. 1977, 55, 1890–1898. [Google Scholar] [CrossRef]
- Takahashi, Y.; Ohtsuka, K. Corona discharges and bubbling in liquid nitrogen. J. Phys. D Appl. Phys. 1975, 8, 165–169. [Google Scholar] [CrossRef]
- Gulyi, G.A. Equipment and Industrial Processes Using the Electrohydraulic Effect; Mashinostroenie: Moscow, Russia, 1977. (In Russian) [Google Scholar]
- Frungel, F.B.A. High Speed Pulse Technology; Academic Press: New York, NY, USA, 1965; Volume I. [Google Scholar]
- Alkhimov, A.P.; Vorob’ev, V.V.; Klimkin, V.F.; Ponomarenko, A.G.; Soloukhin, R.I. The development of electrical discharge in water. Sov. Phys. Dokl. 1971, 15, 959–961. [Google Scholar]
- Zhekul, V.G.; Rakovskii, G.B. Theory of electrical discharge formation in a conducting liquid. Sov. Phys. Tech. Phys. 1983, 28, 4–8. [Google Scholar]
- Ben’kovskii, V.G.; Golubnichii, P.I.; Maslennikov, S.I. Pulsed electrohydrodynamic sonoluminescence accompanying a high-voltage discharge in water. Sov. Phys. Acoust. 1974, 20, 14–15. [Google Scholar]
- Robinson, J.W. Robinson, Finite-difference simulation of an electrical discharge in water. J. Appl. Phys. 1973, 44, 76–81. [Google Scholar] [CrossRef]
- Yanshin, E.V.; Ovchinnikov, I.T.; Vershinin, Y.N. Optical study of manosecond prebreakdown phenomena in water. Sov. Phys. Tech. Phys. 1974, 18, 1303–1306. [Google Scholar]
- Kuskova, N.I. Mechanism of leader propagation in water. Sov. Phys. Tech. Phys. 1983, 28, 591–592. [Google Scholar]
- Clements, J.; Sato, M.; Davis, R. Preliminary investigation of prebreakdown phenomena and chemical reactions using a pulsed high voltage discharge in liquid water. IEEE Trans. Ind. Appl. 1987, 23, 224–235. [Google Scholar] [CrossRef]
- Carter, H.D.; Campbell, A.N. Electric discharges in liquids. I. Arc discharge in water. Trans. Faraday Soc. 1932, 28, 479–494. [Google Scholar] [CrossRef]
- Martin, E.A. Experimental Investigation of a High-Energy Density, High-Pressure Arc Plasma. J. Appl. Phys. 1960, 31, 255–267. [Google Scholar] [CrossRef]
- Yasuoka, K. Progress on direct plasma water treatments. IEEE Trans. Fundam. Mater. 2009, 129, 15–22. [Google Scholar] [CrossRef]
- Locke, B.R.; Sato, M.; Sunka, P.; Hoffmann, M.R.; Chang, J.S. Electrohydraulic discharge and nonthermal plasma for water treatment. Ind. Eng. Chem. Res. 2006, 45, 882–905. [Google Scholar] [CrossRef]
- Malik, M.; Ghaffar, A.; Malik, S. Water purification by electrical discharges. Plasma Sources Sci. Technol. 2001, 10, 82–91. [Google Scholar] [CrossRef]
- Mok, Y.S.; Dors, M.; Mizeraczyk, J. Phenol Oxidation in Aqueous Solution by Gas Phase Corona Discharge. J. Adv. Oxid. Technol. 2006, 9, 139–143. [Google Scholar]
- Mizeraczyk, J.; Dors, M.; Metel, E. Phenol Degradation in Water by Pulsed Streamer Corona Discharge and Fenton Reaction. Int. J. Plasma Environ. Sci. Technol. 2007, 1, 76–81. [Google Scholar]
- Dors, M.; Metel, E.; Mizeraczyk, J.; Marotta, E. Coli bacteria inactivation by pulsed corona discharge in water. Int. J. Plasma Environ. Sci. Technol. 2008, 2, 34–37. [Google Scholar]
- Sun, B.; Sato, M.; Clements, J.S. Optical study of active species produced by a pulsed streamer corona discharge in water. J. Electrostat. 1997, 39, 189–202. [Google Scholar] [CrossRef]
- Sunka, P.; Babický, V.; Clupek, M.; Lukes, P.; Simek, M.; Schmidt, J.; Cernák, M. Generation of chemically active species by electrical discharges in water. Plasma Sources Sci. Technol. 1999, 8, 258–265. [Google Scholar] [CrossRef]
- Joshi, A.A.; Locke, B.R.; Arce, P.; Finney, W.C. Formation of hydroxyl radicals, hydrogen-peroxide, and aqueous electrons by pulsed streamer corona discharge in aqueous-solution. J. Hazard. Mater. 1995, 41, 3–30. [Google Scholar] [CrossRef]
- Bruggeman, P.; Leys, C. Non-thermal plasmas in and in contact with liquids. J. Phys. D Appl. Phys. 2009, 42, 53001. [Google Scholar] [CrossRef]
- Bruggeman, P.J.; Kushner, M.J.; Locke, B.R.; Gardeniers, J.G.E.; Graham, W.G.; Graves, D.B.; Hofman-Caris, R.C.H.M.; Maric, D.; Reid, J.P.; Ceriani, E.; et al. Plasma–liquid interactions: A review and roadmap. Plasma Sources Sci. Technol. 2016, 25, 53002. [Google Scholar] [CrossRef]
- Lesaint, O. Prebreakdown phenomena in liquids: Propagation “modes” and basic physical properties. J. Phys. D Appl. Phys. 2016, 49, 144001. [Google Scholar] [CrossRef]
- Chen, Q.; Chen, Q.; Li, J.; Li, Y. A review of plasma–liquid interactions for nanomaterial synthesis. J. Phys. D Appl. Phys. 2015, 48, 424005. [Google Scholar] [CrossRef]
- Locke, B.R.; Thagard, S.M. Analysis and review of chemical reactions and transport processes in pulsed electrical discharge plasma formed directly in liquid water. Plasma Chem. Plasma Process. 2012, 32, 875–917. [Google Scholar] [CrossRef]
- Locke, B.R.; Shih, K.-Y. Review of the methods to form hydrogen peroxide in electrical discharge plasma with liquid water. Plasma Sources Sci. Technol. 2011, 20, 34006. [Google Scholar] [CrossRef]
- Fridman, A. Plasma Chemistry; Cambridge University Press: Cambridge, UK; New York, NY, USA; Melbourne, Australia; Madrid, Spain; Cape Town, South Africa; Singapore; São Paulo, Brazil; Delhi, India, 2008. [Google Scholar]
- National Research Council and Plasma Science Committee. Plasma Processing of Materials: Scientific Opportunities and Technological Challenges; National Academies Press: Washington, DC, USA, 1991. [Google Scholar]
- Lieberman, M.A.; Lichtenberg, A.J. Principles of Plasma Discharges and Materials Processing; Wiley: New York, NY, USA, 1994. [Google Scholar]
- Moreau, M.; Orange, N.; Feuilloley, M. Non-thermal plasma technologies: New tools for bio-decontamination. Biotechnol. Adv. 2008, 26, 610–617. [Google Scholar] [CrossRef]
- Koo, I.G.; Lee, M.S.; Shim, J.H.; Ahn, J.H.; Lee, W.M. Platinum nanoparticles prepared by a plasma-chemical reduction method. J. Mater. Chem. 2005, 15, 4125. [Google Scholar] [CrossRef]
- Hieda, J.; Saito, N.; Takai, O. Exotic shapes of gold nanoparticles synthesized using plasma in aqueous solution. J. Vac. Sci. Technol. A Vacuum Surfaces Film 2008, 26, 854. [Google Scholar] [CrossRef]
- Sato, S.; Mori, K.; Ariyada, O.; Atsushi, H.; Yonezawa, T. Synthesis of nanoparticles of silver and platinum by microwave-induced plasma in liquid. Surf. Coatings Technol. 2011, 206, 955–958. [Google Scholar] [CrossRef]
- Chen, L.; Iwamoto, C.; Omurzak, E. Synthesis of zirconium carbide (ZrC) nanoparticles covered with graphitic “windows” by pulsed plasma in liquid. RSC Adv. 2011, 1, 1083–1088. [Google Scholar] [CrossRef]
- Richmonds, C.; Sankaran, R. Plasma-liquid electrochemistry: Rapid synthesis of colloidal metal nanoparticles by microplasma reduction of aqueous cations. Appl. Phys. Lett. 2008, 93, 131501. [Google Scholar] [CrossRef]
- Shirafuji, T.; Himeno, Y. Generation of Three-Dimensionally Integrated Micro-Solution Plasma and Its Application to Decomposition of Methylene Blue Molecules in Water. Jpn. J. Appl. Phys. 2013, 52, 11NE03. [Google Scholar] [CrossRef]
- Shirafuji, T.; Ueda, J.; Nakamura, A.; Cho, S.P.; Saito, N.; Takai, O. Gold nanoparticle synthesis using three-dimensionally integrated micro-solution plasmas. Jpn. J. Appl. Phys. 2013, 52, 126202. [Google Scholar] [CrossRef]
- Shirafuji, T.; Noguchi, Y.; Yamamoto, T.; Hieda, J.; Saito, N.; Takai, O.; Tsuchimoto, A.; Nojima, K.; Okabe, Y. Functionalization of multiwalled carbon nanotubes by solution plasma processing in ammonia aqueous solution and preparation of composite material with polyamide. Jpn. J. Appl. Phys. 2013, 52, 125101. [Google Scholar] [CrossRef]
- Toriyabe, Y.; Watanabe, S.; Yatsu, S.; Shibayama, T.; Mizuno, T. Controlled formation of metallic nanoballs during plasma electrolysis. Appl. Phys. Lett. 2007, 91. [Google Scholar] [CrossRef]
- Yu-Tao, Z.; Ying, G.; Teng-Cai, M. Plasma catalytic synthesis of silver nanoparticles. Chin. Phys. Lett. 2011, 28, 105201. [Google Scholar]
- Kim, S.C.; Kim, B.H.; Chung, M.; Ahn, H.G.; Park, Y.K.; Lee, H.; Jung, S.C. Preparation of Aluminum Nanoparticles Using Bipolar Pulsed Electrical Discharge in Water. J. Nanosci. Nanotechnol. 2015, 15, 5350–5353. [Google Scholar] [CrossRef]
- Cho, C.; Choi, Y.W.; Kang, C.; Lee, G.W. Effects of the medium on synthesis of nanopowders by wire explosion process. Appl. Phys. Lett. 2007, 91. [Google Scholar] [CrossRef]
- Huang, X.; Li, Y.; Zhong, X. Effect of experimental conditions on size control of Au nanoparticles synthesized by atmospheric microplasma electrochemistry. Nanoscale Res. Lett. 2014, 9, 572. [Google Scholar] [CrossRef]
- Kaneko, T.; Hatakeyama, R.; Takahashi, S. Plasma process on ionic liquid substrate for morphology controlled nanoparticles. In Ionic Liquids–New Aspects for the Future; IntechOpen: London, UK, 2013. [Google Scholar]
- Seddon, K.R. Ionic Liquids-A taste of the future. Nat. Mater. 2003, 2, 363–365. [Google Scholar] [CrossRef]
- Rogers, R.D.; Seddon, K.R. Ionic liquids—Solvents of the future? Science 2003, 302, 792–793. [Google Scholar] [CrossRef]
- Kaneko, T.; Baba, K.; Harada, T.; Hatakeyama, R. Novel Gas-Liquid Interfacial Plasmas for Synthesis of Metal Nanoparticles. Plasma Process. Polym. 2009, 6, 713–718. [Google Scholar] [CrossRef]
- Kaneko, T.; Chen, Q.; Harada, T.; Hatakeyama, R. Structural and reactive kinetics in gas–liquid interfacial plasmas. Plasma Sources Sci. Technol. 2011, 20, 34014. [Google Scholar] [CrossRef]
- Torimoto, T.; Okazaki, K.I.; Kiyama, T.; Hirahara, K.; Tanaka, N.; Kuwabata, S. Sputter deposition onto ionic liquids: Simple and clean synthesis of highly dispersed ultrafine metal nanoparticles. Appl. Phys. Lett. 2006, 89. [Google Scholar] [CrossRef]
- Xie, Y.; Liu, C. Stability of ionic liquids under the influence of glow discharge plasmas. Plasma Process. Polym. 2008, 5, 239–245. [Google Scholar] [CrossRef]
- Kuwabata, S.; Tsuda, T.; Torimoto, T. Room-temperature ionic liquid. A new medium for material production and analyses under vacuum conditions. J. Phys. Chem. Lett. 2010, 1, 3177–3188. [Google Scholar] [CrossRef]
- Wei, Z.; Liu, C. Synthesis of monodisperse gold nanoparticles in ionic liquid by applying room temperature plasma. Mater. Lett. 2011, 65, 353–355. [Google Scholar] [CrossRef]
- Kareem, T.; Kaliani, A. IV characteristics and the synthesis of ZnS nanoparticles by glow discharge at the metal–ionic liquid interface. J. Plasma Phys. 2012, 78, 189–197. [Google Scholar] [CrossRef]
- Meiss, S.A.; Rohnke, M.; Kienle, L.; Zein El Abedin, S.; Endres, F.; Janek, J. Employing plasmas as gaseous electrodes at the free surface of ionic liquids: Deposition of nanocrystalline silver particles. Chem. Phys. Chem. 2007, 8, 50–53. [Google Scholar] [CrossRef]
- Baba, K.; Kaneko, T.; Hatakeyama, R. Efficient Synthesis of Gold Nanoparticles Using Ion Irradiation in Gas-Liquid Interfacial Plasmas. Appl. Phys. Express. 2009, 2, 35006. [Google Scholar] [CrossRef]
- Kawamura, H.; Moritani, K.; Lto, Y. Discharge electrolysis in molten chloride: Formation of fine silver particles. Plasmas Ions. 1998, 1, 29–36. [Google Scholar] [CrossRef]
- Von Brisinski, N.S.; Höfft, O.; Endres, F. Plasma electrochemistry in ionic liquids: From silver to silicon nanoparticles. J. Mol. Liq. 2014, 192, 59–66. [Google Scholar] [CrossRef]
- Kulbe, N.; Höfft, O.; Ulbrich, A.; el Abedin, S.Z.; Krischok, S.; Janek, J.; Pölleth, M.; Endres, F. Plasma Electrochemistry in 1-Butyl-3-methylimidazolium dicyanamide: Copper Nanoparticles from CuCl and CuCl2. Plasma Process. Polym. 2011, 8, 32–37. [Google Scholar] [CrossRef]
- Mariotti, D.; Patel, J.; Švrček, V.; Maguire, P. Plasma-Liquid Interactions at Atmospheric Pressure for Nanomaterials Synthesis and Surface Engineering. Plasma Process. Polym. 2012, 9, 1074–1085. [Google Scholar] [CrossRef]
- Cho, S.; Bratescu, M.; Saito, N.; Takai, O. Microstructural characterization of gold nanoparticles synthesized by solution plasma processing. Nanotechnology 2011, 22, 455701. [Google Scholar] [CrossRef]
- Bratescu, M.A.; Cho, S.P.; Takai, O.; Saito, N. Size-controlled gold nanoparticles synthesized in solution plasma. J. Phys. Chem. C 2011, 115, 24569–24576. [Google Scholar] [CrossRef]
- Saito, N.; Hieda, J.; Takai, O. Synthesis process of gold nanoparticles in solution plasma. Thin Solid Films 2009, 518, 912–917. [Google Scholar] [CrossRef]
- Lung, J.; Huang, J.; Tien, D.; Liao, C. Preparation of gold nanoparticles by arc discharge in water. J. Alloys Compd. 2007, 434, 655–658. [Google Scholar] [CrossRef]
- Lee, H.; Park, S.H.; Jung, S.-C.; Yun, J.-J.; Kim, S.-J.; Kim, D.-H. Preparation of nonaggregated silver nanoparticles by the liquid phase plasma reduction method. J. Mater. Res. 2013, 28, 1105–1110. [Google Scholar] [CrossRef]
- Bisht, A.; Talebitaher, A. Synthesis of Nanoparticles Using Atmospheric Microplasma Discharge. In Proceedings of the FPPT5 Conference, Singapore, 18–22 April 2011. [Google Scholar]
- Brettholle, M.; Höfft, O.; Klarhöfer, L.; Mathes, S.; Maus-Friedrichs, W.; el Abedin, S.Z.; Krischok, S.; Janek, J.; Endres, F. Plasma electrochemistry in ionic liquids: Deposition of copper nanoparticles. Phys. Chem. Chem. Phys. 2010, 12, 1750–1755. [Google Scholar] [CrossRef]
- Lee, H.; Park, S.H.; Seo, S.; Kim, S.; Kim, S.; Park, Y.; Jung, S. Preparation and Characterization of Copper Nanoparticles via the Liquid Phase Plasma Method. Curr. Nanosci. 2014, 10, 7–10. [Google Scholar] [CrossRef]
- Kim, H.; Lee, H.; Kim, B.H.; Kim, S.; Lee, J.; Ã, S.J. Synthesis Process of Cobalt Nanoparticles in Liquid-Phase Plasma Synthesis Process of Cobalt Nanoparticles in Liquid-Phase Plasma. Jpn. J. Appl. Phys. 2013, 52, 01AN03. [Google Scholar] [CrossRef]
- Amaliyah, N.; Mukasa, S.; Nomura, S.; Toyota, H. Plasma In-liquid Method for Reduction of Zinc Oxide in Zinc Nanoparticle Synthesis. Mater. Res. Express. 2015, 2, 25004. [Google Scholar] [CrossRef]
- Sergiienko, R.; Shibata, E.; Akase, Z.; Suwa, H.; Nakamura, T.; Shindo, D. Carbon encapsulated iron carbide nanoparticles synthesized in ethanol by an electric plasma discharge in an ultrasonic cavitation field. Mater. Chem. Phys. 2006, 98, 34–38. [Google Scholar] [CrossRef]
- Sergiienko, R.; Shibata, E.; Zentaro, A.; Shindo, D.; Nakamura, T.; Qin, G. Formation and characterization of graphite-encapsulated cobalt nanoparticles synthesized by electric discharge in an ultrasonic cavitation field of liquid ethanol. Acta Mater. 2007, 55, 3671–3680. [Google Scholar] [CrossRef]
- Kelgenbaeva, Z.; Omurzak, E.; Takebe, S.; Sulaimankulova, S.; Abdullaeva, Z.; Iwamoto, C.; Mashimo, T. Synthesis of pure iron nanoparticles at liquid–liquid interface using pulsed plasma. J. Nanoparticle Res. 2014, 16, 2603. [Google Scholar] [CrossRef]
- Hattori, Y.; Mukasa, S.; Toyota, H.; Inoue, T.; Nomura, S. Synthesis of zinc and zinc oxide nanoparticles from zinc electrode using plasma in liquid. Mater. Lett. 2011, 65, 188–190. [Google Scholar] [CrossRef]
- Graham, W.G.; Stalder, K.R. Plasmas in liquids and some of their applications in nanoscience. J. Phys. D Appl. Phys. 2011, 44, 174037. [Google Scholar] [CrossRef]
- Saito, G.; Akiyama, T. Nanomaterial Synthesis Using Plasma Generation in Liquid. J. Nanomater. 2015, 16, 299. [Google Scholar] [CrossRef]
- Thompson, M.; Ramsey, M.; Pahlavanpour, B. Water analysis by inductively coupled plasma atomic-emission spectrometry after a rapid pre-concentration. Analyst 1982, 107, 1330–1334. [Google Scholar] [CrossRef]
- Brenner, I.B.; Taylor, H.E. A Critical-Review of Inductively Coupled Plasma-Mass Spectrometry for Geoanalysis, Geochemistry, and Hydrology. Part I. Analytical Performance. Crit. Rev. Anal. Chem. 1992, 23, 355–367. [Google Scholar] [CrossRef]
- Xiong, C.; Jiang, Z.; Hu, B. Speciation of dissolved Fe (II) and Fe (III) in environmental water samples by micro-column packed with N-benzoyl-N-phenylhydroxylamine loaded on microcrystalline naphthalene and determination by electrothermal vaporization inductively coupled plasma-opti. Anal. Chim. Acta 2006, 559, 113–119. [Google Scholar] [CrossRef]
- Maestre, S.E.; Mora, J.; Hernandis, V.; Todoli, J.L. A system for the direct determination of the nonvolatile organic carbon, dissolved organic carbon, and inorganic carbon in water samples through inductively coupled plasma atomic emission spectrometry. Anal. Chem. 2003, 75, 111–117. [Google Scholar] [CrossRef]
- Karandashev, V.K.; Leikin, A.Y.; Khvostikov, V.A.; Kutseva, N.K.; Pirogova, S.V. Water analysis by inductively coupled plasma mass spectrometry. Inorg. Mater. 2016, 52, 1391–1404. [Google Scholar] [CrossRef]
- Popp, M.; Hann, S.; Koellensperger, G. Environmental application of elemental speciation analysis based on liquid or gas chromatography hyphenated to inductively coupled plasma mass spectrometry—A review. Anal. Chim. Acta 2010, 668, 114–129. [Google Scholar] [CrossRef]
- Hill, S.; Bloxham, M.; Worsfold, P. Chromatography Coupled With Inductively Coupled Plasma Atomic Emission Spectrometry and Inductively Coupled Plasma Mass Spectrometry—A review. J. Anal. At. Spectrom. 1993, 8, 499–515. [Google Scholar] [CrossRef]
- Pröfrock, D.; Prange, A. Inductively coupled plasma-mass spectrometry (ICP-MS) for quantitative analysis in environmental and life sciences: A review of challenges, solutions, and trends. Appl. Spectrosc. 2012, 66, 843–868. [Google Scholar] [CrossRef]
- Gilstrap, R.A., Jr. A Colloidal Nanoparticle form of Indium Tin Oxide: System Development and Characterization; Georgia Institute of Technology, School of Materials Science and Engineering: Atlanta, GA, USA, 2009. [Google Scholar]
- Cramer, R.; Corless, S. Liquid ultraviolet matrix-assisted laser desorption/ionization—Mass spectrometry for automated proteomic analysis. Proteomics 2005, 5, 360–370. [Google Scholar] [CrossRef]
- Tholey, A.; Heinzle, E. Ionic (liquid) matrices for matrix-assisted laser desorption/ionization mass spectrometry—Applications and perspectives. Anal. Bioanal. Chem. 2006, 386, 24–37. [Google Scholar] [CrossRef]
- Banerjee, S.; Mazumdar, S. Electrospray Ionization Mass Spectrometry: A Technique to Access the Information beyond the Molecular Weight of the Analyte. Int. J. Anal. Chem. 2012, 2012, 1–40. [Google Scholar] [CrossRef]
- Hahn, D.W.; Omenetto, N. Laser-induced breakdown spectroscopy (LIBS), part II: Review of instrumental and methodological approaches to material analysis and applications to different fields. Appl. Spectrosc. 2012, 66, 347–419. [Google Scholar] [CrossRef]
- Kurniawan, K.H.; Tjia, M.O.; Kagawa, K. Review of laser-induced plasma, its mechanism, and application to quantitative analysis of hydrogen and deuterium. Appl. Spectrosc. Rev. 2014, 49. [Google Scholar] [CrossRef]
- Pardede, M.; Kurniawan, H.; Tjia, M.O.; Ikezawa, K.; Maruyama, T.; Kagawa, K. Spectrochemical Analysis of Metal Elements Electrodeposited from Water Samples by Laser-Induced Shock Wave Plasma Spectroscopy. Appl. Spectrosc. 2001, 55, 1229–1236. [Google Scholar] [CrossRef]
- Li, X.; Zhou, W.; Li, K.; Qian, H.; Ren, Z. Laser ablation fast pulse discharge plasma spectroscopy analysis of Pb, Mg and Sn in soil. Opt. Commun. 2012, 285, 54–58. [Google Scholar] [CrossRef]
- Baude, S.; Broekaert, J.; Delfosse, D. Glow discharge atomic spectrometry for the analysis of environmental samples—A review. J. Anal. At. Spectrom. 2000, 15, 1516–1525. [Google Scholar] [CrossRef]
- Cserfalvi, T.; Mezei, P.; Apai, P. Emission studies on a glow discharge in atmospheric pressure air using water as a cathode. J. Phys. D Appl. Phys. 1993, 26, 2184. [Google Scholar] [CrossRef]
- Marcus, R.K.; Davis, W.C. An atmospheric pressure glow discharge optical emission source for the direct sampling of liquid media. Anal. Chem. 2001, 73, 2903–2910. [Google Scholar] [CrossRef]
- Huang, R.; Zhu, Z.; Zheng, H.; Liu, Z.; Zhang, S. Alternating current driven atmospheric-pressure liquid discharge for the determination of elements with optical emission spectrometry. J. Anal. At. Spectrom. 2011, 26, 1178–1182. [Google Scholar] [CrossRef]
- He, Q.; Zhu, Z.; Hu, S.; Zheng, H.; Jin, L. Elemental determination of microsamples by liquid film dielectric barrier discharge atomic emission spectrometry. Anal. Chem. 2012, 84, 4179–4184. [Google Scholar] [CrossRef]
- Yagov, V.; Korotkov, A.; Zuev, B. Drop-spark discharge: An atomization and excitation source for atomic emission sensors. Mendeleev Commun. 1998, 8, 161–162. [Google Scholar] [CrossRef]
- Yagov, V.V.; Getsina, M.L.; Zuev, B.K. Use of Electrolyte Jet Cathode Glow Discharges as Sources of Emission Spectra for Atomic Emission Detectors in Flow-Injection Analysis. J. Anal. Chem. 2004, 59, 1037–1041. [Google Scholar] [CrossRef]
- Zuev, B.K.; Yagov, V.V.; Getsina, M.L.; Rudenko, B.A. Discharge on boiling in a channel as a new atomization and excitation source for the flow determination of metals by atomic emission spectrometry. J. Anal. Chem. 2002, 57, 907–911. [Google Scholar] [CrossRef]
- Wu, J.; Yu, J.; Li, J.; Wang, J.; Ying, Y. Detection of metal ions by atomic emission spectroscopy from liquid-electrode discharge plasma, Spectrochim. Acta Part B At. Spectrosc. 2007, 62, 1269–1272. [Google Scholar] [CrossRef]
- Staack, D.; Fridman, A.; Gutsol, A.; Gogotsi, Y.; Friedman, G. Nanoscale corona discharge in liquids, enabling nanosecond optical emission spectroscopy. Angew. Chem. Int. Ed. 2008, 47, 8020–8024. [Google Scholar] [CrossRef]
- He, Q.; Zhu, Z.L.; Hu, S.H. Flowing and Nonflowing Liquid Electrode Discharge Microplasma for Metal Ion Detection by Optical Emission Spectrometry. Appl. Spectrosc. Rev. 2013, 49, 249–269. [Google Scholar] [CrossRef]
- Mezei, P.; Cserfalvi, T. Electrolyte cathode atmospheric glow discharges for direct solution analysis. Appl. Spectrosc. Rev. 2007, 42, 573–604. [Google Scholar] [CrossRef]
- Gupta, V.K.; Ali, I.; Saleh, T.A.; Nayak, A.; Agarwal, S. Chemical treatment technologies for waste-water recycling—An overview. RSC Adv. 2012, 2, 6380–6388. [Google Scholar] [CrossRef]
- Goheen, S.C.; Durham, D.E.; McCulloch, M.; Heath, W.O. The degradation of organic dyes by corona discharge. In Proceedings of the Second Internation Symposium Chemical Oxidation Technology Nineties, Nashville, TN, USA, 19–21 Feburary 1992; pp. 356–367. [Google Scholar]
- Maximov, A.I.; Kuzmin, S.M. Some results of the plasma-solution system investigation. In Proceedings of the 5th Symposium on High Pressure Low Temperature Plasma Chemistry Hakone V, Milovy, Brno, Czech Republic, 2–4 September 1996; p. 282. [Google Scholar]
- Jufang, Z.; Jierong, C.; Xiaoyong, L. Remove of Phenolic Compounds in Water by Low-Temperature Plasma: A Review of Current Research. J. Water Resour. Prot. 2009, 1, 99–109. [Google Scholar]
- Jiang, B.; Zheng, J.; Qiu, S.; Wu, M.; Zhang, Q. Review on electrical discharge plasma technology for wastewater remediation. Chem. Eng. J. 2014, 236, 348–368. [Google Scholar] [CrossRef]
- Magureanu, M.; Mandache, N.B.; Parvulescu, V.I. Degradation of pharmaceutical compounds in water by non-thermal plasma treatment. Water Res. 2015, 81, 124–136. [Google Scholar] [CrossRef]
- Magureanu, M.; Bradu, C.; Parvulescu, V.I. Plasma processes for the treatment of water contaminated with harmful organic compounds. J. Phys. D Appl. Phys. 2018, 51, 313002. [Google Scholar] [CrossRef]
- Aziz, K.H.H.; Miessner, H.; Mueller, S.; Mahyar, A.; Kalass, D.; Moeller, D.; Khorshid, I.; Rashid, M.A.M. Comparative study on 2,4-dichlorophenoxyacetic acid and 2,4-dichlorophenol removal from aqueous solutions via ozonation, photocatalysis and non-thermal plasma using a planar falling film reactor. J. Hazard. Mater. 2018, 343, 107–115. [Google Scholar] [CrossRef]
- Hijosa-Valsero, M.; Molina, R.; Schikora, H. Removal of priority pollutants from water by means of dielectric barrier discharge atmospheric plasma. J. Hazard. Mater. 2013, 262, 664–673. [Google Scholar] [CrossRef]
- Brisset, J.L.; Pawlat, J. Chemical Effects of Air Plasma Species on Aqueous Solutes in Direct and Delayed Exposure Modes: Discharge, Post-discharge and Plasma Activated Water. Plasma Chem. Plasma Process. 2016, 36, 355–381. [Google Scholar] [CrossRef]
- Yang, Y.; Cho, Y.; Fridman, A. Plasma Discharge in Liquid: Water Treatment and Applications; CRC Press: Boca Raton, FL, USA, 2012. [Google Scholar]
- Imai, S.; Kumagai, H.; Iwata, M.; Onodera, M.; Suzuki, M. In-Water Plasma Generation on a Liquid Wall Using a Compact Device and Dedicated Power Supply. IEEE Trans. Plasma Sci. 2015, 43, 2166–2173. [Google Scholar] [CrossRef]
- Parvulescu, V.I.; Magureanu, M.; Lukes, P. Plasma Chemistry and Catalysis in Gases and Liquids; Wiley-VCH: Weinheim, Germany, 2012. [Google Scholar]
- Ghodbane, H.; Nikiforov, A.Y.; Hamdaoui, O.; Surmont, P.; Lynen, F.; Willems, G.; Leys, C. Non-thermal plasma degradation of anthraquinonic dye in water: Oxidation pathways and effect of natural matrices. J. Adv. Oxid. Technol. 2014, 17, 372–384. [Google Scholar] [CrossRef]
- Foster, J.E.; Mujovic, S.; Groele, J.; Blankson, I.M. Towards high throughput plasma based water purifiers: Design considerations and the pathway towards practical application. J. Phys. D Appl. Phys. 2018, 51, 293001. [Google Scholar] [CrossRef]
- Feng, L. Advanced Oxidation Processes for the Removal of Residualnon-Steroidal Anti-Inflammatory Pharmaceuticals Fromaqueous Systems; University of Paris-Est: Champs-sur-Marne, France, 2014. [Google Scholar]
- Zhao, X.; Hou, Y.; Liu, H.; Qiang, Z.; Qu, J. Electro-oxidation of diclofenac at boron doped diamond: Kinetics and mechanism. Electrochim. Acta 2009, 54, 4172–4179. [Google Scholar] [CrossRef]
- Kutepov, A.M. Chemical Processes Initiated by a Nonequilibrium in Solutions. Theor. Found. Chem. Eng. 2000, 34, 70–75. [Google Scholar] [CrossRef]
- Hijosa-Valsero, M.; Molina, R.; Schikora, H.; Müller, M.; Bayona, J.M. Removal of cyanide from water by means of plasma discharge technology. Water Res. 2013, 47, 1701–1707. [Google Scholar] [CrossRef]
- Cheremisinoff, N. Handbook of Water and Wastewater Treatment Technologies; Butterworth-Heinemann: Oxford, UK, 2001. [Google Scholar]
- Siemens, W. Ueber die elektrostatische Induction und die Verzögerung des Stroms in Flaschendrähten. Ann. Phys. 1857, 178, 66–122. [Google Scholar] [CrossRef]
- Laroussi, M. The Biomedical Applications of Plasma: A Brief History of the Development of a New Field of Research. IEEE Trans. Plasma Sci. 2008, 36, 1612–1614. [Google Scholar] [CrossRef]
- Boucher, R.M.G. Liquid Phase Disinfection/Sterilization with Microwave Energy. U.S. Patent 6,039,921A, 21 March 2000. [Google Scholar]
- Laroussi, M. Sterilization of tools and infectious waste by plasmas. Bull. Amer. Phys. Soc. Div. Plasma Phys. 1995, 40, 1685–1686. [Google Scholar]
- Laroussi, M. Sterilization of contaminated matter with an atmopsheric pressure plasma. IEEE Trans. Plasma Sci. 1996, 24, 1188–1191. [Google Scholar] [CrossRef]
- Garate, E.; Evans, K.; Gornostaeva, O.; Alexeff, I.; Kang, W.L.; Rader, M.; Wood, T.K. Atmospheric plasma induced sterilization and chemical neutralization. In Proceedings of the IEEE International Conference on Plasma Science, Raleigh, NC, USA, 1–4 June 1998; p. 183. [Google Scholar]
- Kelly-Wintenberg, K.; Montie, T.C.; Brickman, C.; Roth, J.R.; Carr, A.K.; Sorge, K.; Wadsworth, L.C.; Tsai, P.P. Room temperature sterilization of surfaces and fabrics with a one atmosphere uniform glow discharge plasma. J. Ind. Microbiol. Biotechnol. 1998, 20, 69–74. [Google Scholar] [CrossRef]
- Laroussi, M. Biological Decontamination by Non Thermal Plasmas. IEEE Trans. Plasma Sci. 2000, 28, 184–188. [Google Scholar] [CrossRef]
- Kelly-Wintenberg, K.; Roth, J.R.; Montie, T.H. An overview of research using the one atmosphere uniform glow discharge plasma. IEEE Trans. Plasma Sci. 2000, 28, 41–50. [Google Scholar] [CrossRef]
- Richardson, J.P.; Dyer, F.F.; Dobbs, F.C.; Alexeff, I.; Laroussi, M. On the use of the resistive barrier discharge to kill bacteria: Recent results. In Proceedings of the IEEE International Conference on Plasma Science, New Orleans, LA, USA, 4–7 June 2000; p. 109. [Google Scholar]
- De Geyter, N.; Morent, R. Nonthermal plasma sterilization of living and nonliving surfaces. Annu. Rev. Biomed. Eng. 2012, 14, 255–274. [Google Scholar] [CrossRef]
- Rossi, F.; Kylian, O.; Rauscher, H.; Gilliland, D.; Sirghi, L. Use of a low-pressure plasma discharge for the decontamination and sterilization of medical devices. Pure Appl. Chem. 2008, 80, 1939–1951. [Google Scholar] [CrossRef]
- Kostov, K.G.; Rocha, V.; Koga-Ito, C.Y.; Matos, B.M.; Algatti, M.A.; Honda, R.Y.; Kayama, M.E.; Mota, R.P. Bacterial sterilization by a dielectric barrier discharge (DBD) in air. Surf. Coat. Technol. 2010, 204, 2954–2959. [Google Scholar] [CrossRef]
- Choi, J.H.; Han, I.; Baik, H.K.; Lee, M.H.; Han, D.W.; Park, J.C.; Lee, I.S.; Song, K.M.; Lim, Y.S. Analysis of sterilization effect by pulsed dielectric barrier discharge. J. Electrostat. 2006, 64, 17–22. [Google Scholar] [CrossRef]
- Laroussi, M.; Dobbs, F.C.; Wei, Z.; Doblin, M.A.; Ball, L.G.; Moreira, K.R.; Dyer, F.F.; Richardson, J.P. Decontamination of water by excimer UV radiation. IEEE Trans. Plasma Sci. 2002, 30, 1501–1503. [Google Scholar] [CrossRef]
- Hwang, I.; Jeong, J.; You, T.; Jung, J. Water electrode plasma discharge to enhance the bacterial inactivation in water. Biotechnol. Biotechnol. Equip. 2018, 32, 530–534. [Google Scholar] [CrossRef]
- Park, J.H.; Kumar, N.; Park, D.H.; Yusupov, M.; Neyts, E.C.; Verlackt, C.C.W.; Bogaerts, A.; Kang, M.H.; Uhm, H.S.; Choi, E.H.; et al. A comparative study for the inactivation of multidrug resistance bacteria using dielectric barrier discharge and nano-second pulsed plasma. Sci. Rep. 2015, 5, 13849. [Google Scholar] [CrossRef]
- Oehmigen, K.; Hähnel, M.; Brandenburg, R.; Wilke, C.; Weltmann, K.D.; von Woedtke, T. The role of acidification for antimicrobial activity of atmospheric pressure plasma in liquids. Plasma Process. Polym. 2010, 7, 250–257. [Google Scholar] [CrossRef]
- Oehmigen, K.; Winter, J.; Hähnel, M.; Wilke, C.; Brandenburg, R.; Weltmann, K.D.; von Woedtke, T. Estimation of possible mechanisms of escherichia coli inactivation by plasma treated sodium chloride solution. Plasma Process. Polym. 2011, 8, 904–913. [Google Scholar] [CrossRef]
- Von Woedtke, T.; Oehmigen, K.; Brandenburg, R.; Hoder, T.; Wilke, C.; Hähnel, M.; Weltmann, K. Plasma-liquid-interactions: Chemistry and antimicrobial effects. In Plasma Bio-Decontamination, Medicine and Food Security; Springer: Berlin/Heidelberg, Germany, 2012; pp. 67–78. [Google Scholar]
- Ziuzina, D.; Patil, S.; Bourke, P.; Keener, K.; Cullen, P.; Ziuzina, D.; Patil, S.; Cullen, P.J.; Keener, K.M.; Bourke, P. Atmospheric Cold Plasma Inactivation of Escherichia Coli in Liquid Media Inside a Sealed Package. J. Appl. Microbiol. 2013, 114, 778–787. [Google Scholar] [CrossRef]
- Satoh, K.; MacGregor, S.J.; Anderson, J.G.; Woolsey, G.A.; Fouracre, R.A. Pulsed-plasma disinfection of water containing Escherichia coli. Jpn. J. Appl. Phys. 2007, 46, 1137–1141. [Google Scholar] [CrossRef]
- Machala, Z.; Tarabova, B.; Hensel, K.; Spetlikova, E.; Sikurova, L.; Lukes, P. Formation of ROS and RNS in water electro-sprayed through transient spark discharge in air and their bactericidal effects. Plasma Process. Polym. 2013, 10, 649–659. [Google Scholar] [CrossRef]
- Shainsky, N.; Dobrynin, D.; Ercan, U.; Joshi, S.; Ji, H.; Brooks, A.; Cho, Y.; Fridman, A.; Friedman, G. Non-Equilibrium Plasma Treatment of Liquids, Formation of Plasma Acid. In Proceedings of the ISPC-20 20th International Symposium on Plasma Chemistry, Philadelphia, PA, USA, 24–29 July 2011; pp. 5–8. [Google Scholar]
- Ikawa, S.; Kitano, K.; Hamaguchi, S. Effects of pH on bacterial inactivation in aqueous solutions due to low-temperature atmospheric pressure plasma application. Plasma Process. Polym. 2010, 7, 33–42. [Google Scholar] [CrossRef]
- Helmke, A.; Hoffmeister, D.; Mertens, N.; Emmert, S.; Schuette, J.; Vioel, W. The acidification of lipid film surfaces by non-thermal DBD at atmospheric pressure in air. New J. Phys. 2009, 11, 115025. [Google Scholar] [CrossRef]
- Kim, A.; Thayer, D. Radiation-induced cell lethality of Salmonella typhimurium ATCC 14028: Cooperative effect of hydroxyl radical and oxygen. Radiat. Res. 1995, 144, 36–42. [Google Scholar] [CrossRef]
- Thomas, J.K.; Rabani, J.; Matheson, M.S.; Hart, E.J.; Gordon, S. Absorption Spectrum of the Hydroxyl Radical1. J. Phys. Chem. 1966, 70, 2409–2410. [Google Scholar] [CrossRef]
- Marklund, S. Spectrophotometric study of spontaneous disproportionation of superoxide anion radical and sensitive direct assay for superoxide dismutase. J. Biol. Chem. 1976, 251, 7504–7507. [Google Scholar] [PubMed]
- Korshunov, S.; Imlay, J. A potential role for periplasmic superoxide dismutase in blocking the penetration of external superoxide into the cytosol of Gram-negative bacteria. Mol. Microbiol. 2002, 43, 95–106. [Google Scholar] [CrossRef] [PubMed]
- Liu, F.; Sun, P.; Bai, N.; Tian, Y.; Zhou, H. Inactivation of Bacteria in an Aqueous Environment by a Direct-Current, Cold- Atmospheric-Pressure Air Plasma Microjet. Plasma Process. Polym. 2010, 7, 231–236. [Google Scholar] [CrossRef]
- Bai, N.; Sun, P.; Zhou, H.; Wu, H.; Wang, R.; Liu, F.; Zhu, W.; Lopez, J.L.; Zhang, J.; Fang, J. Inactivation of staphylococcus aureus in water by a cold, He/O2 atmospheric pressure plasma microjet. Plasma Process. Polym. 2011, 8, 424–431. [Google Scholar] [CrossRef]
- Shen, J.; Sun, Q.; Zhang, Z.; Cheng, C.; Lan, Y.; Zhang, H.; Xu, Z.; Zhao, Y.; Xia, W.; Chu, P.K. Characteristics of DC gas-liquid phase atmospheric-pressure plasma and bacteria inactivation mechanism. Plasma Process. Polym. 2015, 12, 252–259. [Google Scholar] [CrossRef]
- Kojtari, A.; Ercan, U.K.; Smith, J.; Friedman, G.; Sensenig, R.B.; Tyagi, S.; Joshi, S.G.; Ji, H.F.; Ari, B.D. Chemistry for Antimicrobial Properties of Water Treated With Non-Equilibrium Plasma. Nanomedicine Biother. Discov. 2013, 4, 120. [Google Scholar]
- Lukes, P.; Dolezalova, E.; Sisrova, I.; Clupek, M. Aqueous-phase chemistry and bactericidal effects from an air discharge plasma in contact with water: Evidence for the formation of peroxynitrite through a pseudo-second-order post-dischsrge reaction of H2O2 and HNO2. Plasma Sources Sci. Technol. 2014, 23, 15019. [Google Scholar] [CrossRef]
- Van Gils, C.a.J.; Hofmann, S.; Boekema, B.K.H.L.; Brandenburg, R.; Bruggeman, P.J. Mechanisms of bacterial inactivation in the liquid phase induced by a remote RF cold atmospheric pressure plasma jet. J. Phys. D Appl. Phys. 2013, 46, 175203. [Google Scholar] [CrossRef]
- Takamatsu, T.; Uehara, K.; Sasaki, Y.; Hidekazu, M.; Matsumura, Y.; Iwasawa, A.; Ito, N.; Kohno, M.; Azuma, T.; Okino, A. Microbial inactivation in the liquid phase induced by multigas plasma jet. PLoS ONE 2015, 10. [Google Scholar] [CrossRef]
- Pavlovich, M.J.; Chang, H.-W.; Sakiyama, Y.; Clark, D.S.; Graves, D.B. Ozone correlates with antibacterial effects from indirect air dielectric barrier discharge treatment of water. J. Phys. D Appl. Phys. 2013, 46, 145202. [Google Scholar] [CrossRef]
- Ercan, U.K.; Smith, J.; Ji, H.-F.; Brooks, A.D.; Joshi, S.G. Chemical Changes in Nonthermal Plasma-Treated N-Acetylcysteine (NAC) Solution and Their Contribution to Bacterial Inactivation. Sci. Rep. 2016, 6, 20365. [Google Scholar] [CrossRef] [PubMed]
- Vaze, N.D.; Arjunan, K.P.; Gallagher, M.J.; Vasilets, V.N.; Gutsol, A.; Fridman, A.; Anandan, S. Air and water sterilization using non-thermal plasma. In Proceedings of the PPPS-2007—Pulsed Power Plasma Science, Albuquerque, NM, USA, 17–22 June 2007; pp. 1231–1235. [Google Scholar]
- Yang, Y.; Kim, H.; Starikovskiy, A.; Cho, Y.I.; Fridman, A. Note: An underwater multi-channel plasma array for water sterilization. Rev. Sci. Instrum. 2011, 82, 96103. [Google Scholar] [CrossRef] [PubMed]
- Bakovsky, P.; Fantova, V.; Chumachenko, K. Bacterial Inactivation by Physiologically Relevant Liquids Activated by Atmospheric Pressure Non-Thermal Plasma. Available online: http://poseidon2.feld.cvut.cz/conf/poster/poster2016/proceedings/Section_NS/NS_088_Bakovsky.pdf (accessed on 27 August 2019).
- Boxman, R.L.; Parkansky, N.; Mamane, H.; Meirovitz, M.; Orkabi, Y.; Halperin, T.; Cohen, D.; Orr, N.; Gidalevich, E.; Alterkop, B.; et al. Pulsed submerged arc plasma disinfection of water: Bacteriological results and an exploration of possible mechanisms. In Plasma Assisted Decontamination of Biological and Chemical Agents; Springer: Dordrecht, The Netherlands, 2008; pp. 41–50. [Google Scholar]
- Antoniu, A.; Kurita, H.; Nakajima, T.; Mizuno, A. Safety Evaluation of Non—Thermal Atmospheric Pressure Plasma Liquid Treatment. Mutagenesis 2012, 6, 1–8. [Google Scholar]
- Akishev, Y.; Grushin, M.; Karalnik, V.; Trushkin, N.; Kholodenko, V.; Chugunov, V.; Kobzev, E.; Zhirkova, N.; Irkhina, I.; Kireev, G. Atmospheric-pressure, nonthermal plasma sterilization of microorganisms in liquids and on surfaces. Pure Appl. Chem. 2008, 80, 1953–1969. [Google Scholar] [CrossRef]
- Tang, Y.Z.; Lu, X.P.; Laroussi, M.; Dobbs, F.C. Sublethal and killing effects of atmospheric-pressure, Nonthermal plasma on eukaryotic microalgae in aqueous media. Plasma Process. Polym. 2008, 5, 552–558. [Google Scholar] [CrossRef]
- Gutsol, A.; Vaze, N.D.; Arjunan, K.P.; Gallagher, M.J.; Yang, Y.; Zhu, J.; Vasilets, V.N.; Fridman, A. Plasma for air and water sterilization. In Plasma Assisted Decontamination of Biological and Chemical Agents; Springer: Dordrecht, The Netherlands, 2008; pp. 21–39. [Google Scholar]
- D’Arsonval, J. Nouvel appareil de diathermie intensive. Arch Electr. Med. 1914, 377, 34. [Google Scholar]
- Napp, J.; Daeschlein, G.; Napp, M.; von Podewils, S.; Gumbel, D.; Spitzmueller, R.; Fornaciari, P.; Hinz, P.; Junger, M. On the history of plasma treatment and comparison of microbiostatic efficacy of a historical high-frequency plasma device with two modern devices. GMS Hyg. Infect. Control. 2015, 10, Doc08. [Google Scholar] [PubMed]
- Nagelschmidt, C.F. Uber Hochfrequenzstrome. Berl. Med. Ges. 1909, 24. [Google Scholar]
- Gitomer, S.; Jones, R. Laser produced plasmas in medicine. II. Properties and effects. Plasma Sci. IEEE 1990, 202. [Google Scholar] [CrossRef]
- Gorbanev, Y.; O’Connell, D.; Chechik, V. Non-Thermal Plasma in Contact with Water: The Origin of Species. Chem. A Eur. J. 2016, 22, 3496–3505. [Google Scholar] [CrossRef] [PubMed]
- Jablonowski, H.; Bussiahn, R.; Hammer, M.U.; Weltmann, K.-D.; von Woedtke, T.; Reuter, S. Impact of plasma jet vacuum ultraviolet radiation on reactive oxygen species generation in bio-relevant liquids. Phys. Plasmas 2015, 22, 122008. [Google Scholar] [CrossRef]
- Liu, D.X.; Bruggeman, P.; Iza, F.; Rong, M.Z.; Kong, M.G. Global model of low-temperature atmospheric-pressure He + H2O plasmas. Plasma Sources Sci. Technol. 2010, 19, 025018. [Google Scholar] [CrossRef]
- Darwent, B.D. Bond dissociation energies in simple molecules; NSRDS-NBS31; National Institute of Standards and Technology: Gaithersburg, MD, USA, 1970. [Google Scholar]
- Fridman, G.; Friedman, G.; Gutsol, A.; Shekhter, A.B.; Vasilets, V.N.; Fridman, A. Applied plasma medicine. Plasma Process. Polym. 2008, 5, 503–533. [Google Scholar] [CrossRef]
- Rhoades, R.; Bell, D. Medical Phisiology: Principles for Clinical Medicine; Lippincott Williams & Wilkins: Philadelphia, PA, USA, 2012. [Google Scholar]
- Stoffels, E.; Sakiyama, Y.; Graves, D.B. Cold atmospheric plasma: Charged species and their interactions with cells and tissues. IEEE Trans. Plasma Sci. 2008, 36, 1441–1457. [Google Scholar] [CrossRef]
- Gurtner, G.C.; Werner, S.; Barrandon, Y.; Longaker, M.T. Wound repair and regeneration. Nature 2008, 453, 314–321. [Google Scholar] [CrossRef]
- Kalghatgi, S.; Fridman, G.; Nagaraj, G.; Peddinghaus, M.; Balasubramanian, M.; Brooks, A.; Gutsol, A.; Vasilets, V.; Fridman, G. Mechanism of Blood Coagulation by Non-Equilibrium Atmospheric Pressure Dielectric Barrier Discharge Plasma. In Proceedings of the 18th International Conference Plasma Chemistry, Kyoto, Japan, 26–31 August 2007; pp. 1559–1566. [Google Scholar]
- Chen, C.Y.; Fan, H.W.; Kuo, S.P.; Chang, J.; Pedersen, T.; Mills, T.J.; Huang, C.C. Blood clotting by low-temperature air plasma. IEEE Trans. Plasma Sci. 2009, 37, 993–999. [Google Scholar] [CrossRef]
- Kuo, S.P.; Tarasenko, O.; Chang, J.; Popovic, S.; Chen, C.Y.; Fan, H.W.; Scott, A.; Lahiani, M.; Alusta, P.; Drake, J.D.; et al. Contribution of a portable air plasma torch to rapid blood coagulation as a method of preventing bleeding. New J. Phys. 2009, 11, 115016. [Google Scholar] [CrossRef]
- Kuo, S. Air plasma for medical applications. J. Biomed. Sci. Eng. 2012, 5, 481–495. [Google Scholar] [CrossRef][Green Version]
- Raiser, J.; Zenker, M. Argon plasma coagulation for open surgical and endoscopic applications: State of the art. J. Phys. D Appl. Phys. 2006, 39, 3520–3523. [Google Scholar] [CrossRef]
- Malick, K. Clinical applications of argon plasma coagulation in endoscopy. Gastroenterol. Nurs. 2006, 29, 386–391. [Google Scholar] [CrossRef] [PubMed]
- Arjunan, K.P.; Clyne, A.M. Hydroxyl radical and hydrogen peroxide are primarily responsible for dielectric barrier discharge plasma-induced angiogenesis. Plasma Process. Polym. 2011, 8, 1154–1164. [Google Scholar] [CrossRef]
- Tiede, R.; Hirschberg, J.; Daeschlein, G.; von Woedtke, T.; Vioel, W.; Emmert, S. Plasma applications: A dermatological view. Contrib. to Plasma Phys. 2014, 54, 118–130. [Google Scholar] [CrossRef]
- Maisch, T.; Shimizu, T.; Li, Y.F.; Heinlin, J.; Karrer, S.; Morfill, G.; Zimmermann, J.L. Decolonisation of MRSA, S. aureus and E. coli by cold-atmospheric plasma using a porcine skin model in vitro. PLoS ONE 2012, 7, e34610. [Google Scholar] [CrossRef] [PubMed]
- Foster, W.K.; Moy, R.L.; Fincher, E.F. Advances in plasma skin regeneration. J. Cosmet. Dermatol. 2008, 7, 169–179. [Google Scholar] [CrossRef] [PubMed]
- Kronemyer, B. Portrait PSR3 Technology Provides True Skin Regeneration, European Aesthetic Buyers Guide; Spring: Berlin/Heidelberg, Germany, 2006. [Google Scholar]
- Bogle, M.A.; Arndt, K.A.; Dover, J.S. Evaluation of plasma skin regeneration technology in low-energy full-facial rejuvenation. Arch. Dermatol. 2007, 143, 168–174. [Google Scholar] [CrossRef]
- Mertens, N.; Helmke, A.; Goppold, A. March. S: Emmert, A. Kaemling, and D. Wandke. In Proceedings of the Second International Conference Plasma Medicine, Boulder, CO, USA, 5–8 January 2009. [Google Scholar]
- Heinlin, J.; Isbary, G.; Stolz, W.; Morfill, G.; Landthaler, M.; Shimizu, T.; Steffes, B.; Nosenko, T.; Zimmermann, J.L.; Karrer, S. Plasma applications in medicine with a special focus on dermatology. J. Eur. Acad. Dermatol. Venereol. 2011, 25, 1–11. [Google Scholar] [CrossRef] [PubMed]
- Pennisi, E. A mouthful of microbes: Oral biologists are devouring new data on the composition, activity, and pathogenic potential of microbes in the mouth, the gateway to the gut. Science (80-) 2005, 307, 1899–1902. [Google Scholar] [CrossRef]
- Moore, W.; Moore, L. The bacteria of periodontal diseases. Periodontology 2000, 5, 66–77. [Google Scholar] [CrossRef]
- Hoffmann, C.; Berganza, C.; Zhang, J. Cold Atmospheric Plasma: Methods of production and application in dentistry and oncology. Med. Gas Res. 2013, 3, 21. [Google Scholar] [CrossRef]
- Li, Y. Tooth bleaching using peroxide-containing agents: Current status of safety issues. Compend. Contin. Educ. Dent. 1998, 19, 783–786. [Google Scholar]
- Kawamoto, K.; Tsujimoto, Y. Effects of the hydroxyl radical and hydrogen peroxide on tooth bleaching. J. Endod. 2004, 30, 45–50. [Google Scholar] [CrossRef] [PubMed]
- Lee, H.; Kim, G.; Kim, J.; Park, J.; Lee, J. Tooth bleaching with nonthermal atmospheric pressure plasma. J. Endod. 2009, 35, 587–591. [Google Scholar] [CrossRef] [PubMed]
- Sun, P.; Pan, J.; Tian, Y.; Bai, N.; Wu, H.; Wang, L.; Yu, C.; Zhang, J.; Zhu, W.; Becker, K.H.; et al. Tooth whitening with hydrogen peroxide assisted by a direct-current cold atmospheric-pressure air plasma microjet. IEEE Trans. Plasma Sci. 2010, 38, 1892–1896. [Google Scholar]
- Pan, J.; Sun, P.; Tian, Y.; Zhou, H.; Wu, H.; Bai, N.; Liu, F.; Zhu, W.; Zhang, J.; Becker, K.H.; et al. A novel method of tooth whitening using cold plasma microjet driven by direct current in atmospheric-pressure air. IEEE Trans. Plasma Sci. 2010, 38, 3143–3151. [Google Scholar] [CrossRef]
- Kim, M.S.; Koo, I.G.; Choi, M.Y.; Jung, J.C.; Eldali, F.; Lee, J.K.; Collins, G.J. Correlated Electrical and Optical Studies of Hybrid Argon Gas–Water Plasmas and their Application to Tooth Whitening. Plasma Process. Polym. 2012, 9, 339–345. [Google Scholar] [CrossRef]
- Park, J.K.; Nam, S.H.; Kwon, H.C.; Mohamed, A.A.H.; Lee, J.K.; Kim, G.C. Feasibility of nonthermal atmospheric pressure plasma for intracoronal bleaching. Int. Endod. J. 2011, 44, 170–175. [Google Scholar] [CrossRef] [PubMed]
- Nam, S.H.; Lee, H.W.; Cho, S.H.; Lee, J.K.; Jeon, Y.C.; Kim, G.C. High-efficiency tooth bleaching using non-thermal atmospheric pressure plasma with low concentration of hydrogen peroxide. J. Appl. Oral Sci. 2013, 21, 265–270. [Google Scholar] [CrossRef] [PubMed]
- Claiborne, D.; Mccombs, G.; Lemaster, M.; Akman, M.A.; Laroussi, M. Low-temperature atmospheric pressure plasma enhanced tooth whitening: The next-generation technology. Int. J. Dent. Hyg. 2014, 12, 108–114. [Google Scholar] [CrossRef] [PubMed]
- Arora, V.; Nikhil, V.; Suri, N.K.; Arora, P. Cold atmospheric plasma (CAP) in dentistry. Dentistry 2014, 4, 1. [Google Scholar] [CrossRef]
- Fridman, G.; Shereshevsky, A.; Jost, M.M.; Brooks, A.D.; Fridman, A.; Gutsol, A.; Vasilets, V.; Friedman, G. Floating Electrode Dielectric Barrier Discharge Plasmain Air Promoting Apoptotic Behavior in Melanoma Skin Cancer Cell Lines, Plasma Chem. Plasma Process. 2007, 27, 163–176. [Google Scholar] [CrossRef]
- Kieft, I.E.; Darios, D.; Roks, A.J.M.; Stoffels, E. Plasma treatment of mammalian vascular cells: A quantitative description. IEEE Trans. Plasma Sci. 2005, 33, 771–775. [Google Scholar] [CrossRef]
- Stoffels, E.; Roks, A.J.M.; Deelman, L.E. Delayed Effects of Cold Atmospheric Plasma on Vascular Cells. Plasma Process. Polym. 2008, 5, 599–605. [Google Scholar] [CrossRef]
- Kiaris, H.; Schally, A. Apoptosis versus necrosis: Which should be the aim of cancer therapy? Exp. Biol. Med. 1999, 221, 87–88. [Google Scholar] [CrossRef]
- Joh, H.; Kim, S.; Chung, T.; Leem, S. Reactive oxygen species-related plasma effects on the apoptosis of human bladder cancer cells in atmospheric pressure pulsed plasma jets. Appl. Phys. Lett. 2012, 101, 53703. [Google Scholar]
- Kim, G.J.; Kim, W.; Kim, K.T.; Lee, J.K. DNA damage and mitochondria dysfunction in cell apoptosis induced by nonthermal air plasma. Appl. Phys. Lett. 2010, 96, 21502. [Google Scholar] [CrossRef]
- Keidar, M.; Shashurin, A.; Volotskova, O.; Stepp, M.A.; Srinivasan, P.; Sandler, A.; Trink, B. Cold atmospheric plasma in cancer therapy. Phys. Plasmas. 2013, 20, 057101. [Google Scholar] [CrossRef]
- Chen, Z.; Cheng, X.; Lin, L.; Keidar, M. Cold atmospheric plasma discharge in water and its potential use in cancer therapy. J. Phys. D Appl. Phys. 2017, 50, 15208. [Google Scholar] [CrossRef]
- Dobrynin, D.; Fridman, G.; Friedman, G.; Fridman, A. Physical and biological mechanisms of direct plasma interaction with living tissue. New J. Phys. 2009, 11, 115020. [Google Scholar] [CrossRef]
- Kalghatgi, S.; Kelly, C.M.; Cerchar, E.; Torabi, B.; Alekseev, O.; Fridman, A.; Friedman, G.; Azizkhan-Clifford, J. Effects of non-thermal plasma on mammalian cells. PLoS ONE 2011, 6. [Google Scholar] [CrossRef]
- Shekhter, A.B.; Serezhenkov, V.A.; Rudenko, T.G.; Pekshev, A.V.; Anatoly, F. Beneficial effect of gaseous nitric oxide on the healing of skin wounds. Nitric Oxide 2005, 12, 210–219. [Google Scholar] [CrossRef] [PubMed]
- Shekhter, A.; Kabisov, R.; Pekshev, A.; Kozlov, N.; Perov, Y.L. Experimental and clinical validation of plasmadynamic therapy of wounds with nitric oxide. Bull. Exp. Biol. Med. 1998, 126, 829–834. [Google Scholar] [CrossRef]
- Schlegel, J.; Köritzer, J.; Boxhammer, V. Plasma in cancer treatment. Clin. Plasma Med. 2013, 1, 2–7. [Google Scholar] [CrossRef]
- Graves, D.B. Reactive Species From Cold Atmospheric Plasma: Implications for Cancer Therapy. Plasma Process. Polym. 2014, 11, 1120–1127. [Google Scholar] [CrossRef]
- Kim, J.Y.; Wei, Y.; Li, J.; Foy, P.; Hawkins, T.; Ballato, J.; Kim, S.O. Cancer Therapy: Single-Cell-Level Microplasma Cancer Therapy (Small 16/2011). Small 2011, 7, 2290. [Google Scholar] [CrossRef]
- Tanaka, H.; Iseki, S.; Nakamura, K.; Hayashi, M.; Tanaka, H.; Kondo, H.; Kajiyama, H.; Kano, H.; Kikkawa, F. Selective killing of ovarian cancer cells through induction of apoptosis by nonequilibrium atmospheric pressure plasma. Appl. Phys. Lett. 2012, 100, 113702. [Google Scholar] [CrossRef]
- Utsumi, F.; Kajiyama, H.; Nakamura, K.; Tanaka, H.; Ishikawa, F.K.K.; Kondo, H.; Kano, H.; Hori, M. Effect of Indirect Nonequilibrium Atmospheric Pressure Plasma on Anti-Proliferative Activity against Chronic Chemo-Resistant Ovarian Cancer Cells In Vitro and In Vivo. PLoS ONE 2013, 8, e81576. [Google Scholar] [CrossRef] [PubMed]
- Wende, K.; Williams, P.; Dalluge, J.; van Gaens, W.; Aboubakr, H.; Bischof, J.; von Woedtke, T.; Goyal, S.M.; Weltmann, K.-D.; Bogaerts, A.; et al. Identification of the biologically active liquid chemistry induced by a nonthermal atmospheric pressure plasma jet. Biointerphases 2015, 10, 29518. [Google Scholar] [CrossRef]
- Bergemann, C.; Hoppe, C.; Karmazyna, M.; Hoentsch, M.; Eggert, M. Physicochemical Analysis of Argon Plasma-Treated Cell Culture Medium. In Plasma Science and Technology-Progress in Physical States and Chemical Reactions; Mieno, T., Ed.; IntechOpen: London, UK, 2016; pp. 183–200. [Google Scholar]
- Yan, D.; Talbot, A.; Nourmohammadi, N.; Cheng, X. Principles of using cold atmospheric plasma stimulated media for cancer treatment. Sci. Rep. 2015, 5, 18339. [Google Scholar] [CrossRef]
- Weiss, M.; Gümbel, D.; Hanschmann, E.; Mandelkow, R. Cold atmospheric plasma treatment induces anti-proliferative effects in prostate cancer cells by redox and apoptotic signaling pathways. PLoS ONE 2015, 10, e0130350. [Google Scholar] [CrossRef]
- Nguyen, N.H.; Park, H.J.; Yang, S.S.; Choi, K.S.; Lee, J.-S. Anti-cancer efficacy of nonthermal plasma dissolved in a liquid, liquid plasma in heterogeneous cancer cells. Sci. Rep. 2016, 6, 29020. [Google Scholar] [CrossRef]
- Chen, Z.; Lin, L.; Cheng, X.; Gjika, E.; Keidar, M. Treatment of gastric cancer cells with non-thermal atmospheric plasma generated in water. Biointerphases 2016, 11, 31010. [Google Scholar] [CrossRef]
- Bernal, M.; Verdaguer, D.; Badosa, J.; Abadía, A.; Llusià, J.; Peñuelas, J.; Núñez-Olivera, E.; Llorens, L. Effects of enhanced UV radiation and water availability on performance, biomass production and photoprotective mechanisms of Laurus nobilis seedlings. Environ. Exp. Bot. 2015, 109, 264–275. [Google Scholar] [CrossRef]
- Teramura, A.H. Effects of ultraviolet-B radiation on the growth and yield of crop plants. Physiol. Plant. 1983, 58, 415–427. [Google Scholar] [CrossRef]
- Karabourniotis, G.; Bornman, J.F. Penetration of UV-A, UV-B and blue light through the leaf trichome layers of two xeromorphic plants, olive and oak, measured by optical fibre microprobes. Physiol. Plant. 1999, 105, 655–661. [Google Scholar] [CrossRef]
- Cen, Y.; Bornman, J. The response of bean plants to UV-B radiation under different irradiances of background visible light. J. Exp. Bot. 1990, 41, 1489–1495. [Google Scholar] [CrossRef]
- Ohta, T. Plasma in Agriculture. In Cold Plasma Food Agriculture Fundamentals Application, 1st ed.; Cullen, P.J., Misra, N.N., Schlüter, O., Eds.; Academic Press: Cambridge, MA, USA, 2016; p. 380. [Google Scholar]
- Ito, M.; Ohta, T.; Hori, M. Plasma agriculture. J. Korean Phys. Soc. 2012, 60, 937–943. [Google Scholar] [CrossRef]
- Randeniya, L.K.; de Groot, G.J.J.B. Non-Thermal Plasma Treatment of Agricultural Seeds for Stimulation of Germination, Removal of Surface Contamination and Other Benefits: A Review. Plasma Process. Polym. 2015, 12, 608–623. [Google Scholar] [CrossRef]
- Surowsky, B.; Schlüter, O.; Knorr, D. Interactions of Non-Thermal Atmospheric Pressure Plasma with Solid and Liquid Food Systems: A Review. Food Eng. Rev. 2014, 7, 82–108. [Google Scholar] [CrossRef]
- Krapivina, S.A.; Filippov, A.K.; Levitskaya, T.N.; Bakhvalov, A. Gas Plasma Treatment of Plant Seeds. U.S. Patent 5,281,315, 24 January 1994. [Google Scholar]
- Volin, J.C.; Denes, F.S.; Young, R.A.; Park, S.M.T. Modification of Seed Germination Performance through Cold Plasma Chemistry Technology. Crop Sci. 2000, 40, 1706–1718. [Google Scholar] [CrossRef]
- Lynikiene, S.; Pozeliene, A. Influence of corona discharge field on seed viability and dynamics of germination. Int. Agrophysics. 2006, 20, 195. [Google Scholar]
- Bormashenko, E.; Shapira, Y.; Grynyov, R.; Whyman, G.; Bormashenko, Y.; Drori, E. Interaction of cold radiofrequency plasma with seeds of beans (Phaseolus vulgaris). J. Exp. Bot. 2015, 66, 4013–4021. [Google Scholar] [CrossRef]
- Wang, L.Y.; Huang, Z.L.; Li, G.; Zhao, H.X.; Xing, X.H.; Sun, W.T.; Li, H.P.; Gou, Z.X.; Bao, C.Y. Novel mutation breeding method for Streptomyces avermitilis using an atmospheric pressure glow discharge plasma. J. Appl. Microbiol. 2010, 108, 851–858. [Google Scholar] [CrossRef]
- Padureanu, S. The Influence of Cold Plasma Produced by Glidarc Without Water Vapor, Upon the Cells Division in Triticum Aestivum L. Agron. Ser. Sci. Res. Stiint. Ser. Agron. 2012, 55, 119–124. [Google Scholar]
- Zhang, H.; Ma, D.; Qiu, R.; Tang, Y.; Du, C. Non-thermal plasma technology for organic contaminated soil remediation: A review. Chem. Eng. J. 2017, 313, 157–170. [Google Scholar] [CrossRef]
- Aggelopoulos, C.A.; Tsakiroglou, C.D.; Ognier, S.; Cavadias, S. Non-aqueous phase liquid-contaminated soil remediation by ex situ dielectric barrier discharge plasma. Int. J. Environ. Sci. Technol. 2015, 12, 1011–1020. [Google Scholar] [CrossRef]
- Aggelopoulos, C.A. Atmospheric pressure dielectric barrier discharge for the remediation of soil contaminated by organic pollutants. Int. J. Environ. Sci. Technol. 2016, 13, 1731–1740. [Google Scholar] [CrossRef]
- Wang, T.; Qu, G.; Li, J.; Liang, D.; Hu, S. Depth dependence of p-nitrophenol removal in soil by pulsed discharge plasma. Chem. Eng. J. 2014, 239, 178–184. [Google Scholar] [CrossRef]
- Lou, J.; Lu, N.; Li, J.; Wang, T.; Wu, Y. Remediation of chloramphenicol-contaminated soil by atmospheric pressure dielectric barrier discharge. Chem. Eng. J. 2012, 180, 99–105. [Google Scholar] [CrossRef]
- Stryczewska, H.D.; Ebihara, K.; Takayama, M.; Gyoutoku, Y.; Tachibana, M. Non-thermal plasma-based technology for soil treatment. Plasma Process. Polym. 2005, 2, 238–245. [Google Scholar] [CrossRef]
- Park, D.P.; Davis, K.; Gilani, S.; Alonzo, C.A.; Dobrynin, D.; Friedman, G.; Fridman, A.; Rabinovich, A.; Fridman, G. Reactive nitrogen species produced in water by non-equilibrium plasma increase plant growth rate and nutritional yield. Curr. Appl. Phys. 2013, 13, S19–S29. [Google Scholar] [CrossRef]
- Sivachandiran, L.; Khacef, A. Enhanced seed germination and plant growth by atmospheric pressure cold air plasma: Combined effect of seed and water treatment. RSC Adv. 2017, 7, 1822–1832. [Google Scholar] [CrossRef]
- Zhou, R.; Zhou, R.; Zhang, X.; Zhuang, J.; Yang, S. Effects of Atmospheric-Pressure N2, He, Air, and O2 Microplasmas on Mung Bean Seed Germination and Seedling Growth. Sci. Rep. 2016, 6, 32603. [Google Scholar] [CrossRef]
- Marsili, L.; Espie, S.; Anderson, J.G.; MacGregor, S.J. Plasma inactivation of food-related microorganisms in liquids, Radiat. Phys. Chem. 2002, 65, 507–513. [Google Scholar]
- Goulet, V.; Hedberg, C.; le Monnier, A.; de Valk, H. Increasing incidence of listeriosis in France and other European countries. Emerg. Infect. Dis. 2008, 14, 734–740. [Google Scholar] [CrossRef]
- Zhao, Y.-M.; de Alba, M.; Sun, D.-W.; Tiwari, B. Principles and recent applications of novel non-thermal processing technologies for the fish industry—A review. Crit. Rev. Food Sci. Nutr. 2018, 59, 1–15. [Google Scholar] [CrossRef]
- Zhang, Z.H.; Wang, L.H.; Zeng, X.A.; Han, Z.; Brennan, C.S. Non-thermal technologies and its current and future application in the food industry: A review. Int. J. Food Sci. Technol. 2019, 54, 1–13. [Google Scholar] [CrossRef]
- Jiang, B.; Zheng, J.; Wu, M. Nonthermal Plasma for Effluent and Waste Treatment. Cold Plasma in Food and Agriculture: Fundamentals and Applications; Elsevier Inc.: Amsterdam, The Netherlands, 2016. [Google Scholar]
- Yasui, S.; Seki, S.; Yoshida, R.; Shoji, K.; Terazoe, H. Sterilization of Fusarium oxysporum by treatment of non-thermalequilibrium plasma in nutrient solution. Jpn. J. Appl. Phys. 2016, 55, 01AB01. [Google Scholar] [CrossRef]
- Gurol, C.; Ekinci, F.Y.; Aslan, N.; Korachi, M. Low Temperature Plasma for decontamination of E. coli in milk. Int. J. Food Microbiol. 2012, 157, 1–5. [Google Scholar] [CrossRef]
- Kim, H.J.; Yong, H.I.; Park, S.; Kim, K.; Choe, W.; Jo, C. Microbial safety and quality attributes of milk following treatment with atmospheric pressure encapsulated dielectric barrier discharge plasma. Food Control. 2015, 47, 451–456. [Google Scholar] [CrossRef]
- Takai, E.; Kitano, K.; Kuwabara, J.; Shiraki, K. Protein inactivation by low-temperature atmospheric pressure plasma in aqueous solution. Plasma Process. Polym. 2012, 9, 77–82. [Google Scholar] [CrossRef]
- Tammineedi, C.V.; Choudhary, R.; Perez-Alvarado, G.C.; Watson, D.G. Determining the effect of UV-C, high intensity ultrasound and nonthermal atmospheric plasma treatments on reducing the allergenicity of α-casein and whey proteins. LWT-Food Sci. Technol. 2013, 54, 35–41. [Google Scholar] [CrossRef]
- Pankaj, S.K.; Misra, N.N.; Cullen, P.J. Kinetics of tomato peroxidase inactivation by atmospheric pressure cold plasma based on dielectric barrier discharge. Innov. Food Sci. Emerg. Technol. 2013, 19, 153–157. [Google Scholar] [CrossRef]
- Shi, X.M.; Zhang, G.J.; Wu, X.L.; Li, Y.X.; Ma, Y.; Shao, X.J. Effect of low-temperature plasma on microorganism inactivation and quality of freshly squeezed orange juice. IEEE Trans. Plasma Sci. 2011, 39, 1591–1597. [Google Scholar] [CrossRef]
- Yong, H.I.; Kim, H.; Cheo, J.H.; Jeon, H.; Jung, S.; Park, S.; Choe, W.; Jo, C. The Use of Plasma-Treated Water as a Source of Nitrite for Curing Ham. Meat Sci. 2015, 108, 132–137. [Google Scholar]
- Korachi, M.; Ozen, F.; Aslan, N.; Vannini, L.; Guerzoni, M.E.; Gottardi, D.; Ekinci, F.Y. Biochemical changes to milk following treatment by a novel, cold atmospheric plasma system. Int. Dairy J. 2015, 42, 64–69. [Google Scholar] [CrossRef]
- Kovačević, D.B.; Putnik, P.; Dragović-Uzelac, V.; Pedisić, S.; Jambrak, A.R.; Herceg, Z. Effects of cold atmospheric gas phase plasma on anthocyanins and color in pomegranate juice. Food Chem. 2016, 190, 317–323. [Google Scholar] [CrossRef]
- Ma, T.J.; Lan, W.S. Effects of non-thermal plasma sterilization on volatile components of tomato juice. Int. J. Environ. Sci. Technol. 2015, 12, 3767–3772. [Google Scholar] [CrossRef]
- Kovačević, D.B.; Kljusurić, J.G.; Putnik, P.; Vukušić, T.; Herceg, Z.; Dragović-Uzelac, V. Stability of polyphenols in chokeberry juice treated with gas phase plasma. Food Chem. 2016, 212, 323–331. [Google Scholar] [CrossRef]
- Ponraj, S.B.; Sharp, J.; Kanwar, J.R.; Sinclair, A.J.; Kviz, L.; Nicholas, K.R.; Dai, X.J. Sterilization of cow’ s milk using liquid plasma. In Proceedings of the 22nd International Symposium on Plasma Chemistry, Antwerp, Belgium, 5–10 July 2015; pp. 5–7. [Google Scholar]
- Garofulić, I.E.; Jambrak, A.R.; Milošević, S.; Dragović-Uzelac, V.; Zorić, Z.; Herceg, Z. The effect of gas phase plasma treatment on the anthocyanin and phenolic acid content of sour cherry Marasca (Prunus cerasus var. Marasca) juice. LWT-Food Sci. Technol. 2015, 62, 894–900. [Google Scholar]
- Van Nguyen, D. Experimental Studies of Streamer Phenomena in Long Oil Gaps; Norwegian University of Science and Technology: Trondheim, Norway, 2013. [Google Scholar]
- Zakaria, I.H.; Ahmad, M.H.; Arief, Y.Z.; Awang, N.A.; Ahmad, N.A. Characteristics of mineral oil-based nanofluids for power transformer application. Int. J. Electr. Comput. Eng. 2017, 7, 1530–1537. [Google Scholar] [CrossRef]
- Qin, C.; He, Y.; Shi, B.; Zhao, T.; Lv, F.; Cheng, X. Experimental study on breakdown characteristics of transformer oil influenced by bubbles. Energies 2018, 11, 634. [Google Scholar] [CrossRef]
- Mankowski, J.; Dickens, J. High voltage subnanosecond breakdown. IEEE Trans. Plasma Sci. 1998, 26, 874–881. [Google Scholar] [CrossRef]
- Haidara, M.; Denat, A. Electron multiplication in liquid cyclohexane and propane: An estimation of the ionization coefficient. In Proceedings of the IEEE 10th International Conference on Conduction and Breakdown in Dielectric Liquids, Grenoble, France, 10–14 September 1990; pp. 397–401. [Google Scholar]
- Dumitrescu, L.; Lesaint, O.; Bonifaci, N.; Denat, A. Study of streamer inception in cyclohexane with a sensitive charge measurement technique under impulse voltage. J. Electrostat. 2001, 53, 135–146. [Google Scholar] [CrossRef]
- Gournay, P.; Lesaint, O. A study of the inception of positive streamers in cyclohexane and pentane. J. Phys. D Appl. Phys. 1993, 26, 1966–1974. [Google Scholar] [CrossRef]
- Chadband, W.G. On variations in the propagation of positive discharges between transformer oil and silicone fluids. J. Phys. D Appl. Phys. 1980, 13, 1299–1307. [Google Scholar] [CrossRef]
- Yamashita, H.; Amano, H.; Mori, T. Optical observation of pre-breakdown and breakdown phenomena in transformer oil. J. Phys. D Appl. Phys. 1977, 10, 1753. [Google Scholar] [CrossRef]
- Yamashita, H.; Amano, H. Pre-breakdown current and light emission in transformer oil. IEEE Trans. Electr. Insul. 1985, 2, 247–255. [Google Scholar] [CrossRef]
- Rafiq, M.; Lv, Y.; Li, C. A Review on Properties, Opportunities, and Challenges of Transformer Oil-Based Nanofluids. J. Nanomater. 2016, 2016, 24. [Google Scholar] [CrossRef]
- Liao, T.W.; Anderson, J.G. Propagation Mechanism of Impulse Corona and Breakdown in Oil. Trans. Am. Inst. Electr. Eng. Part I Commun. Electron. 1953, 72, 641–648. [Google Scholar] [CrossRef]
- Hizal, E.M.; Dincer, S. Breakdown time lags and prebreakdown phenomena in transformer oil, effects of hydrostatic pressure. J. Electrostat. 1982, 12, 333–343. [Google Scholar] [CrossRef]
- Linhjell, D.; Lundgaard, L.; Berg, G. Streamer propagation under impulse voltage in long point-plane oil gaps. IEEE Trans. Dielectr. Electr. Insul. 1994, 1, 447–458. [Google Scholar] [CrossRef]
- Lesaint, O.; Massala, G. Positive streamer propagation in large oil gaps: Experimental characterization of propagation modes. IEEE Trans. Dielectr. Electr. Insul. 1998, 5, 360–370. [Google Scholar] [CrossRef]
- Lundgaard, L.; Linhjell, D.; Berg, G.; Sigmond, S. Propagation of positive and negative streamers in oil with and without pressboard interfaces. IEEE Trans. Dielectr. Electr. Insul. 1998, 5, 388–395. [Google Scholar] [CrossRef]
- Badent, R.; Kist, K.; Schwab, A.J. Prebreakdown phenomena in insulating oil at large gap distances. In Proceedings of the 1994 4th International Conference Properties Applications of Dielectric Matererials, Queensland, Australia, 3–8 July 1994; pp. 103–106. [Google Scholar]
- Rain, P.; Lesaint, O. Prebreakdown Phenomena in Mineral Oil under Step and ac Voltage in large-gap divergent fields. IEEE Trans. Dielectr. Electr. Insul. 1994, 1, 692–701. [Google Scholar] [CrossRef]
- Lesaint, O.; Saker, A.; Gournay, P.; Tobazeon, R.; Aubin, J.; Mailhot, M. Streamer propagation and breakdown under ac voltage in very large oil gaps. IEEE Trans. Dielectr. Electr. Insul. 1998, 5, 351–359. [Google Scholar] [CrossRef]
- Massala, G.; Lesaint, O. Positive streamer propagation in large oil gaps: Electrical properties of streamers. IEEE Trans. Dielectr. Electr. Insul. 1998, 5, 371–380. [Google Scholar] [CrossRef]
- Saker, A.; Lesaint, O.; Tobazeon, R. Propagation of streamers in mineral oil at large distances. In Proceedings of the IEEE Conference on Electrical Insulation and Dielectric Phenomena, Arlington, TX, USA, 23–26 October 1994; pp. 889–894. [Google Scholar] [CrossRef]
- Massala, G.; Lesaint, O. A comparison of negative and positive streamers in mineral oil at large gaps. J. Phys. D Appl. Phys. 2001, 34, 1525. [Google Scholar] [CrossRef]
- Chadband, W.; Sufian, T. Experimental support for a model of positive streamer propagation in liquid insulation. IEEE Trans. Electr. Insul. 1985, 2, 239–246. [Google Scholar] [CrossRef]
- Hebner, R.E.; Kelley, E.F.; Forster, E.O.; FitzPatrick, G.J. Observation of prebreakdown and breakdown phenomena in liquid hydrocarbons II. Non-uniform field conditions. IEEE Trans. Electr. Insul. 1985, 2, 281–292. [Google Scholar] [CrossRef]
- Lesaint, O.; Jung, M. On the relationship between streamer branching and propagation in liquids: Influence of pyrene in cyclohexane. J. Phys. D Appl. Phys. 2000, 33, 1360–1368. [Google Scholar] [CrossRef]
- Ingebrigtsen, S.; Lundgaard, L.E.; Åstrand, P.O. Effects of additives on prebreakdown phenomena in liquid cyclohexane: II. Streamer propagation. J. Phys. D Appl. Phys. 2007, 40, 5624. [Google Scholar] [CrossRef]
- Linhjell, D.; Ingebrigtsen, S.; Lundgaard, L.E.; Unge, M. Streamers in long point-plane gaps in cyclohexane with and without additives under step voltage. In Proceedings of the IEEE International Conference on Dielectric Liquids, Trondheim, Norway, 26–30 June 2011; pp. 1–5. [Google Scholar]
- Dung, N.V.; Høidalen, H.K.; Linhjell, D.; Lundgaard, L.E.; Unge, M. Effects of reduced pressure and additives on streamers in white oil in long point-plane gap. J. Phys. D Appl. Phys. 2013, 46, 255501. [Google Scholar] [CrossRef]
- Duy, C.T.; Lesaint, O.; Denat, A.; Bonifaci, N. Streamer propagation and breakdown in natural ester at high voltage. IEEE Trans. Dielectr. Electr. Insul. 2009, 16, 1582–1594. [Google Scholar] [CrossRef]
- Liu, Q.; Wang, Z.D. Streamer characteristic and breakdown in synthetic and natural ester transformer liquids with pressboard interface under lightning impulse voltage. IEEE Trans. Dielectr. Electr. Insul. 2011, 18, 1908–1917. [Google Scholar] [CrossRef]
- Hueso, J.L.; Rico, V.J.; Cotrino, J.; Jime, J.M.; Gonza, A.R. Water plasmas for the revalorisation of heavy oils and cokes from petroleum refining. Environ. Sci. Technol. 2009, 43, 2557–2562. [Google Scholar] [CrossRef] [PubMed]
- Prieto, G.; Okumoto, M.; Takashima, K.; Katsura, S.; Mizuno, A.; Prieto, O.; Gay, C.R. Nonthermal plasma reactors for the production of light hydrocarbon olefins from heavy oil. Braz. J. Chem. Eng. 2003, 20, 57–61. [Google Scholar] [CrossRef]
- Prieto, G.; Okumoto, M.; Shimano, K. Reforming of heavy oil using nonthermal plasma. IEEE Trans. Ind. Appl. 2001, 37, 1464–1467. [Google Scholar] [CrossRef]
- Honorato, H.D.; Silva, R.C.; Piumbini, C.K.; Zucolotto, C.G.; De Souza, A.A.; Cunha, A.G.; Emmerich, F.G.; Lacerda, V.; De Castro, E.V.; Bonagamba, T.J.; et al. 1 H low-and high-field NMR study of the effects of plasma treatment on the oil and water fractions in crude heavy oil. Fuel 2012, 92, 62–68. [Google Scholar] [CrossRef]
- Massala, G.; Lesaint, O. On the correlation between propagation mode, charge and shape of streamers in mineral oil. In Proceedings of the ICDL’96. 12th International Conference on Conduction and Breakdown in Dielectric Liquids, Roma, Italy, 15–19 July 1996; pp. 255–258. [Google Scholar]
- Kamata, Y.; Kako, Y. Flashover Characteristics of Extremely Long Gaps in Transformer Oil under Non-Uniform Field Conditions. IEEE Trans. Electr. Insul. 1980, 15, 18–26. [Google Scholar] [CrossRef]
- Trinh, N.G.; Saker, A. Interpretation of the Physical Mechanisms in the Breakdown of Long Gaps in Transformer Oil. In Proceedings of the International Conference on Conduction and Breakdown in Dielectric Liquids, Roma, Italy, 15–19 July 1996; pp. 287–291. [Google Scholar]
- Tian, C.; Chao, Y.; Ying, Y.; Yan-Hong, D. Photoluminescence of silicone oil treated by fluorocarbon plasma. Chin. Phys. B 2012, 21, 97802. [Google Scholar]
- Rezaei, F.; Nikiforov, A.; Morent, R.; de Geyter, N. Plasma Modification of Poly Lactic Acid Solutions to Generate High Quality Electrospun PLA Nanofibers. Sci. Rep. 2018, 8, 2241. [Google Scholar] [CrossRef]
- Rezaei, F.; Gorbanev, Y.; Chys, M.; Nikiforov, A.; van Hulle, S.W.H.; Cos, P.; Bogaerts, A.; de Geyter, N. Investigation of plasma-induced chemistry in organic solutions for enhanced electrospun PLA nanofibers. Plasma Process. Polym. 2018, e1700226. [Google Scholar] [CrossRef]
- Colombo, V.; Fabiani, D.; Focarete, M.L.; Gherardi, M.; Gualandi, C.; Laurita, R.; Zaccaria, M. Atmospheric Pressure Non-Equilibrium Plasma Treatment to Improve the Electrospinnability of Poly( L -Lactic Acid) Polymeric Solution. Plasma Process. Polym. 2014, 11, 247–255. [Google Scholar] [CrossRef]
- Shi, Q.; Vitchuli, N.; Nowak, J.; Lin, Z.; Guo, B.; McCord, M.; Bourham, M.; Zhang, X. Atmospheric Plasma Treatment of Pre-Electrospinning Polymer Solution: A Feasible Method to Improve Electrospinnability. J. Polym. Sci. Part B Polym. Phys. 2011, 49, 115–122. [Google Scholar] [CrossRef]
- Shi, Q.; Vitchuli, N.; Nowak, J.; Caldwell, J.M.; Breidt, F.; Bourham, M.; Zhang, X.; McCord, M. Durable antibacterial Ag/polyacrylonitrile (Ag/PAN) hybrid nanofibers prepared by atmospheric plasma treatment and electrospinning. Eur. Polym. J. 2011, 47, 1402–1409. [Google Scholar] [CrossRef]
- Grande, S.; van Guyse, J.; Nikiforov, A.Y.; Onyshchenko, I.; Asadian, M.; Morent, R.; Hoogenboom, R.; de Geyter, N. Atmospheric Pressure Plasma Jet Treatment of Poly-ε-caprolactone Polymer Solutions To Improve Electrospinning. ACS Appl. Mater. Interfaces 2017, 9, 33080–33090. [Google Scholar] [CrossRef]
- Chen, J.P.; Su, C.H. Surface modification of electrospun PLLA nanofibers by plasma treatment and cationized gelatin immobilization for cartilage tissue engineering. Acta Biomater. 2011, 7, 234–243. [Google Scholar] [CrossRef]
- Zhang, Y.; Li, J.; An, G.; He, X. Highly porous SnO2 fibers by electrospinning and oxygen plasma etching and its ethanol-sensing properties. Sens. Actuators B Chem. 2010, 144, 43–48. [Google Scholar] [CrossRef]
- Yoon, Y.I.; Moon, H.S.; Lyoo, W.S.; Lee, T.S.; Park, W.H. Superhydrophobicity of cellulose triacetate fibrous mats produced by electrospinning and plasma treatment. Carbohydr. Polym. 2009, 75, 246–250. [Google Scholar] [CrossRef]
- Wang, H.; Tang, H.; He, J.; Wang, Q. Fabrication of aligned ferrite nanofibers by magnetic-field-assisted electrospinning coupled with oxygen plasma treatment. Mater. Res. Bull. 2009, 44, 1676–1680. [Google Scholar] [CrossRef]
- Ghobeira, R.; Philips, C.; de Naeyer, V.; Declercq, H.; Cools, P.; de Geyter, N.; Cornelissen, R.; Morent, R. Comparative study of the surface properties and cytocompatibility of plasma-treated poly-ϵ-caprolactone nanofibers subjected to different sterilization methods. J. Biomed. Nanotechnol. 2017, 13, 699–716. [Google Scholar] [CrossRef]
- Asadian, M.; Dhaenens, M.; Onyshchenko, I.; de Waele, S.; Declercq, H.; Cools, P.; Devreese, B.; Deforce, D.; Morent, R.; de Geyter, N. Plasma Functionalization of Polycaprolactone Nanofibers Changes Protein Interactions with Cells, Resulting in Increased Cell Viability. ACS Appl. Mater. Interfaces 2018, 10, 41962–41977. [Google Scholar] [CrossRef] [PubMed]
- Asadian, M.; Onyshchenko, I.; Thiry, D.; Cools, P.; Declercq, H.; Snyders, R.; Morent, R.; de Geyter, N. Thiolation of polycaprolactone (PCL) nanofibers by inductively coupled plasma (ICP) polymerization: Physical, chemical and biological properties. Appl. Surf. Sci. 2019, 479, 942–952. [Google Scholar] [CrossRef]
- Grande, S.; Cools, P.; Asadian, M.; van Guyse, J.; Onyshchenko, I.; Declercq, H.; Morent, R.; Hoogenboom, R.; de Geyter, N. Fabrication of PEOT/PBT Nanofibers by Atmospheric Pressure Plasma Jet Treatment of Electrospinning Solutions for Tissue Engineering. Macromol. Biosci. 2018, 18, 1800309. [Google Scholar] [CrossRef]

| No | NPs | Size of NPs (nm) | Raw Material | Liquid | Plasma Source | Description | Reference |
|---|---|---|---|---|---|---|---|
| 1 | Ag, Au, Ni, Ti | 100 | Metal wire cathode | K2CO3 | Atmospheric glow discharge | Cathodic plasma electrolysis. Voltage: 120–160 V, time: 10, 30 min. | [71] |
| 2 | Ag | 3.5 | AgNO3 | Ethanol | Atmospheric pulsed DBD jet | Ar glow discharge on the solution. Voltage: 5 kV, gas flow: 0.3–1 L/min, gap: 3–5 mm, frequency: 67.5 kHz. | [72] |
| 3 | Ag | 5–50 | AgNO3 | Ultrapure water | Bipolar pulsed discharge | High frequency discharge directly in liquid phase with needle to needle electrode geometry. Voltage: 250 V, pulse frequency: 30 kHz, pulse width: 2 µs, gap: 0.2 mm. | [96] |
| 4 | Ag | 7–13 | AgNO3 | Water | Atmospheric DC micro-plasma discharge | He plasma on the solution. Voltage: 0–15 kV, gas flow: 25 standard cubic centimeter per minute (sccm), gap: 3–4 mm, time: 30 s–10 min. | [97] |
| 5 | Ag | 57 | Silver wire | Water | Arc discharge | Wire explosion in water. Voltage: 12 kV, capacity: 10 µF. | [74] |
| 6 | Al2O3 | 10–100 | AlCl3 | Water | Bipolar pulsed discharge | High frequency discharge directly in liquid phase with needle to needle electrode geometry. Voltage: 250 V, pulse frequency: 30 kHz, pulse width: 5 µs, gap: 0.3 mm. | [73] |
| 7 | Au | 10–180 | HAuCl4 | Water | DC micro-plasma | He or Ar micro-plasma on the solution. Voltage: 0.8–2 kV, current: 1–5 mA, gap: 0.5–1.5 mm, gas flow: 25 sccm, time: 10 min. | [91] |
| 8 | Au | 20, 50 | HAuCl4 | Water | Pulsed DC discharge | Glow discharge in aqueous solution. Voltage: 1.6, 3.2 kV, pulse frequency: 15 kHz, pulse width: 2 µs, gap: 0.3 mm. | [64] |
| 9 | Au | 10 | HAuCl4 | Water | Pulsed DC discharge | Ar plasma into the solution. Voltage: 960 V, current: 0.5 A, pulse frequency: 15 kHz, pulse width: 2 µs, time: 10 min, gap: 0.3 mm. | [92] |
| 10 | Au | 2–10 | HAuCl4 | Water | Pulsed DC discharge | Plasma is generated in the aqueous gold solution with needle to needle electrode geometry. Frequency: 10 kHz, pulse width: 250 ns, time: 30 min, gap: 0.2 mm. | [93] |
| 11 | Au | 150 | HAuCl4 | Water | Pulsed DC discharge | Discharge directly in liquid phase. Voltage: 1.6, 2.4, 3.2 kV, gap: 0.3 mm, pulse frequency: 15 kHz, pulse width: 2 µs, time: 5–45 min. | [94] |
| 12 | Au | 32.75, 36.87 | HAuCl4 | Water | DC micro-plasma | He plasma on the liquid. Voltage: 2 kV, current: 8 mA, time: 15 min, gap: 2 mm. | [75] |
| 13 | Au | 10–65 | Gold wire electrode | Water | DC arc discharge | Submerged gold wires in deionized water as electrodes with needle to needle geometry. Voltage: 20–40 V, pulse width: 10 µs, current: 4 A, gap: few microns. | [95] |
| 14 | Co3C | 4–70 | Cobalt plate and tip | Ethanol | DC plasma discharge | Ar plasma in the ultrasonic cavitation field. Voltage: 55 V, current: 3 A, gap: 1 mm, power: 165 W, time: 15 min. | [103] |
| 15 | Co | 10–100 | CoCl2 | Pure water | Bipolar pulsed discharge | High frequency discharge directly in liquid phase with needle to needle electrode geometry. Voltage: 250 V, pulse frequency: 30 kHz, pulse width: 5 µs, gap: 0.3 mm, time: 10–120 min. | [100] |
| 16 | Cu | 11–26 | Copper wire | Ionic liquid | DC discharge | Cathode glow discharge on the liquid in Ar atmosphere. Voltage: 450–500 V, current: 10 mA, time: 30 min, pressure: 100 Pa. | [98] |
| 17 | Cu | 5–50 | CuCl2 | Ultrapure water | Bipolar pulsed discharge | High frequency discharge directly in liquid phase with needle to needle electrode geometry. Voltage: 250 V, gap: 0.3 mm, pulse frequency: 30 kHz, pulse width: 5 µs. | [99] |
| 18 | Fe3C, χ-Fe2.5C | 5–600 | Iron tip | Ethanol | Low power DC discharge | Ar plasma in the ultrasonic cavitation field. Voltage: 55 V, current: 1.58 A, gap: 1 mm. | [102] |
| 19 | Fe | 9.5–21.6 | Iron electrodes | Toluene/water | Pulsed AC discharge | Discharge directly in liquid phase. Voltage: 100 V, current: 6 A, gap: 1 mm, pulse width: 10 µs. | [104] |
| 20 | Zn | 30–200 | ZnO powder | Ethanol | Microwave plasma | Plasma in the liquid. Frequency: 2.45 GHz in TE10 mode, power: 235 W, time: 10 min. | [101] |
| 21 | Zn | 10–200 | Zinc plate | Water, alcohol | Microwave plasma | Plasma in the liquid. Power: 250 W, time: 30 s, gap: 1 mm. | [105] |
| 22 | ZrC | 10 | Zirconium electrode | Ethanol | Pulsed AC discharge | Discharge directly in liquid phase. Current: 20 A, pulse frequency: 60 Hz, pulse width: 3 µs, gap: 0–1 mm, time: 1 h. | [66] |
| Chemical | Solubility | Reaction | Oxidation Potential (V) |
|---|---|---|---|
| OH• | Half lifetime: few hundreds µs | 2.81 | |
| O(3P) | Lifetime ~10−5 s | 2.42 | |
| O3 | 2.27 mmol/L or 109 mg/L | 2.07 | |
| H2O2 | Infinite | 1.78 | |
| HO2• | Less reactive than the matching anion | 1.50 | |
| O2 | 0.28 mmol/L or 8.9 mg/L | 1.23 | |
| O2•− | – | – | 1.00 |
| H2O | Infinite | 0.40 | |
| ONOOH/ONO2− | Acid half lifetime ≈ 20 ms | 2.10 | |
| NO3− | Fairly soluble | 0.96 | |
| NO | 1.55 mmol/L at 37 °C | – | 0.90 |
| N2 | 0.49 mmol/L or 13.8 mg/L | – | – |
| NO2 | Low solubility (hydrolysis) | 0.90 | |
| NO2− | Hydrolysis/disproportionation at low pH | – | |
| H | – | – | 2.30 |
| F2 | – | 2.87 | |
| MnO4− | – | 1.52 | |
| Cl2 | Insoluble | 1.36 | |
| Fe3+ | – | 0.77 |
| No | Microorganism | Inactivation Efficacy | Liquid | Plasma Source | Carrier Gas | Description | Reference |
|---|---|---|---|---|---|---|---|
| 1 | E. coli | ~5 log reduction | Water | Pulsed corona discharge | – | Point-plane electrode system in water. Vp-p: 25 kV, currentp-p: 400 A, pulse duration: 1.8 µs, pulse frequency: 1–50 Hz, gap: 0.5–5 cm, energy per pulse: 2 J. | [195] |
| 2 | E. coli | ~4 log reduction | Water | Pulsed DC discharge | – | Single- and double-layer multi-channel plasma discharge array in water. Voltage: 23 kV, pulse duration: 3 µs, current: 20 A. | [196] |
| 3 | E. coli | ~105 times reduction | Water | Pulsed discharge plasma | O2/N2 and O2/Ar | Plasma was generated using a planar high voltage electrode above the water surface. Gap: 12 mm, voltage: 27 kV, pulse frequency: 50 Hz, conductivity of water: 500 µS/cm, liquid volume: 900 mL, gas flow: 2.5 L/min. | [190] |
| 4 | E. coli | 6–7 log reduction | Maximum recovery diluent (MRD), PBS | Atmospheric DBD plasma | Ambient air | Direct and indirect plasma treatment on the solutions. Voltage: 40 kV, treatment time: 10–300 s, gap: 10 mm (direct), 120–160 mm (indirect), liquid volume: 100 µL. | [176] |
| 5 | E. coli | ~3 log reduction | Distilled water, saline | DC positive streamer discharge | – | Point-hollow plane electrode system was used to generate indirect plasma on the solutions. Liquid volume: 6.5 mL, treatment time: 1–9 min, gap: 6 mm, voltage: 15 kV. | [197] |
| 6 | S. aureus | 2 log reduction | Distilled water | Atmospheric DC bubbling discharge | Ar | Plasma was generated in a quartz glass tube immersed in water. Gas flow: 2.5 L/h, gap: 20 mm, treatment time: 0–40 min, voltage: 6.5 kV, current: 150 mA, power: 0.4 W. | [188] |
| 7 | E. coli | 7 log reduction | NAC | Atmospheric DBD plasma | Ambient air | Plasma was generated above the liquid. Liquid volume: 1 mL, treatment time: 1–3 min, gap: 2 mm, voltage: 31.4 kV, frequency: 15 kHz, power density: 0.29 W/cm2. | [194] |
| 8 | E. coli | 7 log reduction | Distilled water | Atmospheric floating-electrode DBD plasma | – | Gap: 2 mm, liquid volume: 1 mL, treatment time: 0–3 min. | [189] |
| 9 | E. coli, L. citreum | More than 106 times reduction | Distilled water | Pulsed plasma jet | He | Gap: 20 mm, liquid volume: 500 µL, gas flow: 2.0 L/min, frequency: 13.9 kHz, voltage: −3.5–5 kV, treatment time: 0–300 s. | [180] |
| 10 | S. aureus | 100% | Water, water/LB culture media, water/bacteria suspension | Atmospheric DC micro-jet plasma | Air | Plasma was produced in the liquid. Gas flow: 2–3 slm, voltage: 400–600 V, current: 0–35 mA, liquid volume: 20 mL, treatment time: 0–20 min. | [186] |
| 11 | P. aeruginosa | – | Distilled water, saline | Atmospheric RF plasma jet | Ar | Plasma on the solutions. Gas flow: 1.5 slm, frequency: 13.56 MHz, power: 1.4 W, liquid volume: 100 µL, gap: 8 mm. | [191] |
| 12 | S. aureus, E. faecalis, E. coli, P. aeruginosa, MRSA, M. terrae, M. abscessus, B. cereus, C. albicans, T. mentagrophytes, A. niger | In case of S. aureus (for other cases please refer to the article): CO2 and N2: more than 6 log reduction at 60 s O2: 3 log reduction at 120 s Ar and mock air: less than 1 log reduction at 120 s | Bacterial suspension in PBS | AC Multi-gas plasma jet | CO2, N2, Ar, O2, mock air | Frequency: 16 kHz, voltage: 9 kV, power: 10 W, gas flow: 1 L/min, gap: 6 mm. | [192] |
| 13 | E. coli | 100% | Deionized water | Pulsed DBD plasma | Air, O2 | Liquid volume: 10 mL, gap: 1.5 mm, voltage: 17 kV, pulse frequency: 1.7 kHz, treatment time: 0–30 min. | [179] |
| 14 | E. coli | – | Tap water | Pulsed submerged arc discharge | – | Liquid volume: 50 mL, pulse frequency: 100 Hz, voltage: 80 V, pulse duration: 20 µs, treatment time: 5–60 s. | [198] |
| 15 | E. coli | Nearly no bacterial inactivation in Ar/ considerable reduction in air | Distilled water, NaCl | Surface DBD plasma | Ar, ambient air | Gap: 5 mm, gas flow: 0.5 slm, voltage: 10 kV (air), 3 kV (Ar), liquid volume: 5 mL, treatment time: 0–30 s. | [175] |
| 16 | E. coli and λDNA | 100% | Citric acid buffer, TE buffer | Atmospheric pulsed plasma jet | He | Gas flow: 2 L/min, voltage: 15 kV, pulse frequency: 3 kHz, pulse duration: 2.8 µs, gap: 40 mm, liquid volume: 100 µL, treatment time: 0–120 s. | [199] |
| 17 | E. coli, B. subtilis, biofilms | 100% | Physiological solution | DC pulsed streamer-spark discharge | – | Multi point-plane geometry was used to generate bubbling discharge. Gap: 10–15 mm, power: 30, 60 W, treatment time: 0–420 s. | [200] |
| 18 | S. aureus, Multidrug resistant bacteria | NPP: 4–5 log reduction DBD: 3 log reduction | Saline solution | Nano-second pulsed plasma and AC DBD surface plasma in Ar | – | NPP: Needle to needle electrode geometry in the liquid. Voltage: 6 kV, current: 0.7 kA. DBD surface plasma on the solution: Voltage: 0.6 kV, current: 14 mA, treatment time: 5 min. | [172] |
| 19 | A. sanguinea, S. trochoidea, H. triquetra | – | Algal culture | Remote DBD plasma | Air | Gap: 25 mm, voltage: 9 kV, frequency: 60 Hz, gas flow: 4 L/min, liquid volume: 1 mL, treatment time: 40–60 s. | [201] |
| 20 | E. coli, B. atrophaeus, S. aureus | – | Water, physiological saline, PBS | Pulsed surface DBD plasma | Ambient air | Indirect DBD plasma treatment. Gap: 5 mm, voltage: 10 kV, frequency: 20 kHz, liquid volume: 1.5, 5, 10 mL, treatment time: 0–30 min. | [173] |
| 21 | E. coli | 5.5 log reduction | Physiological saline, PBS | Indirect AC DBD plasma | Air | Frequency: 10 kHz, voltage: 2–6 kV, power: 0.3–7 W, liquid volume: 150 µL, treatment time: 30–300 s. | [193] |
| 22 | E. coli | ~6 log reduction | Water, buffered and non-buffered saline solutions | DC transient spark discharge | Air | Electro-spraying in point-plane electrode system. Gap: 10 mm, voltage: 14 kV, liquid flow rate: 0.5 mL/min, treatment time: 5 min. | [178] |
| 23 | S. aureus | More than 99% reduction | Water | Atmospheric DC plasma micro-jet | He/O2 | Plasma immersed in water. Gas volume ratio: He/O2: 98/2%, gas flow: 2.5 slm, voltage: 400 V, current: 35 mA, treatment time: 0–16 min. | [187] |
| 24 | E. coli | ~5 log reduction | Water | Pulsed discharge | Air, O2, N2 | Multi-needle electrode system on the liquid. Liquid volume: 120 mL, gap: 4 mm, gas flow: 0.5–4 L/min, treatment time: 0–900 s, voltage: 17 kV. | [177] |
| Name | Wavelength (nm) | Energy (eV) |
|---|---|---|
| Ultraviolet A (UVA) | 400–315 | 3.94–3.10 |
| Ultraviolet B (UVB) | 315–280 | 4.43–3.94 |
| Ultraviolet C (UVC) | 280–200 | 6.20–4.43 |
| Vacuum ultraviolet (VUV) | 200–100 | 12.4–6.20 |
| Reaction | Bond Dissociation Energy | Dissociation Wavelength (nm) | |
|---|---|---|---|
| kJ/mol | eV | ||
| 197 | 2.04 | 607.8 | |
| 356 | 3.69 | 336 | |
| 374.5 | 3.88 | 319.5 | |
| 428 | 4.44 | 279.2 | |
| 435.9 | 4.52 | 274.3 | |
| 498.3 | 5.16 | 240.3 | |
| 498.7 | 5.17 | 239.8 | |
| 532.2 | 5.52 | 224.6 | |
| 631.6 | 6.55 | 189.3 | |
| 945.4 | 9.80 | 126.5 | |
| 1076.5 | 11.16 | 111.1 | |
| No | Biological Target | Treatment Type | Liquid | Plasma Source | Carrier Gas | Description | Reference |
|---|---|---|---|---|---|---|---|
| 1 | Endothelial cells, vascular smooth muscle cells | Direct | Culture medium | Atmospheric RF plasma needle | He | RF glow discharge. Frequency: 13.56 MHz, gas flow: 2 L/min, liquid volume: 10–60 µL, gap: 3 mm, voltage: 226–280 V, treatment time: 30–540 s. | [243] |
| 2 | Human Melanoma skin cancer cells | Direct | Culture medium | FE-DBD plasma | Air | Voltage: 10–30 kV, gap: 3 mm, power: 4 W, liquid volume: 200 µL, treatment time: 5–30 s. | [242] |
| 3 | Endothelial cells, vascular smooth muscle cells | Direct | Culture medium | Atmospheric RF plasma needle | He | Indirect RF glow discharge. Frequency: 13.56 MHz, gas flow: 2 L/min, gap: 1 mm, treatment time: 2–50 s. | [244] |
| 4 | Blood | Direct | Blood | AC plasma spray | Air | Frequency: 60 Hz, power: 170 W. | [218] |
| 5 | Human bladder cancer cells | Direct | Culture medium | Pulsed DC plasma jet | He/O2 | Gas flow: He/O2: 100, 500/5, 10, 20 sccm, voltage: 1.2–1.8 kV, frequency: 20, 50 kHz, liquid volume: 0.2–1 mL, treatment time: 10, 20 s, gap: 6 mm. | [246] |
| 6 | Mouse melanoma cancer cells | Direct | Culture medium | Cold surface-type DBD discharge | Ambient air | Voltage: 4.2 kV, power: 4.26 W, treatment time: 10, 30, 50 s, gap: 5 mm. | [247] |
| 7 | Mammalian breast epithelial cells | Direct and indirect | Culture medium | AC pulsed DBD plasma | Air | Voltage: 20 kV, pulse duration: 1.65 µs, rise time: 5 V/ns, gap: 2 mm, liquid volume: 100 µL. | [251] |
| 8 | Murine melanoma and fibroblast tumor cells | Direct | Culture medium | Micro-plasma jet employing a hollow-core glass optical fiber | He | Gas flow: 10 sccm, frequency: 32 kHz, voltage: 17 kV, gap: 5 mm, treatment time: 10 s. | [256] |
| 9 | Human ovarian cancer cells | Direct | Culture medium | Non-equilibrium atmospheric plasma | Ar | Gas flow: 2 slm, liquid volume: 2 mL, gap: 15 mm, treatment time: 30–300 s, voltage: 10 kV, frequency: 60 Hz. | [257] |
| 10 | Mouse epithelial ovarian cancer cells | Indirect | Culture medium | Non-equilibrium atmospheric plasma | Ar | Gas flow: 2 slm, liquid volume: 100 µL, gap: 15 mm, treatment time: 30–300 s, voltage: 10 kV, frequency: 60 Hz. | [258] |
| 11 | CRFK feline kidney cells | Indirect and direct | Physiological liquid | RF atmospheric plasma jet | Ar | Gas flow: 1.5 slm, frequency: 13.7 MHz, liquid volume: 100 µL. | [259] |
| 12 | Mouse liver epithelial cells | Indirect | Various culture media | Atmospheric plasma jet | Ar | Gas flow: 1.9 slm, frequency: 1.1 MHz, voltage: 2–6 kV, liquid volume: 100 µL, gap: 1 mm, treatment time: 60, 120 s. | [260] |
| 13 | Human U87 cancer cells, human MDA-MB-231 cancer cells, MCF-7 cancer cells | Indirect | Cell culture media | DC cold plasma jet | He | Gap: 3 cm, liquid volume: 1 mL, time: 0.5–2 min, gas flow: 4.7 L/min, input voltage: 11.5 V, output voltage: 3.16 kV, power: 5 W. | [261] |
| 14 | Human epithelial PC cell lines LNCaP and PC-3 | Indirect | Sespended cells in RPMI medium | DC cold plasma jet | Ar | Liquid volume: 500 µL, time: 10 s, gas flow: 3 L/min, voltage: 65 V, frequency: 1.1 MHz. | [262] |
| 15 | Breast cancer cells | Indirect | Deionized water | Cold plasma jet | Ar, He, N2 | Voltage: 2–5 kV, frequency: 30 kHz, gas flow: 0.3 L/min. | [249] |
| 16 | Human cervical carcinoma cell line HeLa, sarcoma U2OS cells, breast cancer cells | Indirect | DMEM cell culture medium | Micro-plasma jet | Air | Gas flow: 10 L/min, time: 5 min. | [263] |
| 17 | Human gastric cancer cells | Indirect | Deionized water | Cold plasma jet | Ar | Gas flow: 0.4 L/min, time: 5–30 min, voltage: 8 kV, average current: 0.23 mA, frequency: 6.25 kHz. | [264] |
| No | Food Product | Investigated Microorganism | Plasma Source | Carrier Gas | Description | Reference |
|---|---|---|---|---|---|---|
| 1 | Commercial UHT and raw milk | E. coli | Atmospheric AC corona discharge | Air | Plasma inside the solution. Voltage: 9 kV, current: 90 mA, time: 3–30 min. | [294] |
| 2 | Milk | E. coli, L. monocytogenes, S. typhimurium | Atmospheric DBD plasma | Air | Power: 250 W, frequency: 15 kHz, time: 5, 10 min. | [295] |
| 3 | Hen egg | Hen egg white lysozyme in aqueous solution | Low frequency atmospheric AC plasma jet | He/O2 | Plasma inside the solution. Gas flow: He/O2 = 0.50/0.15 L/min, time: 3 min. | [296] |
| 4 | Milk | α-casein, β-lactoglobulin, α-lactalbumin proteins in PBS | Atmospheric RF plasma | Ar | Gas flow: 30.7 L/min, frequency: 13.56 MHz. | [297] |
| 5 | Tomato | Tomato peroxides, as a model enzyme | Atmospheric DBD plasma | Air | Gap: 26 mm, voltage: 30, 40, 50 kV, time: 1–5 min. | [298] |
| 6 | Fresh orange juice | Vitamin C, S. aureus, E. coli, C. albicans | Atmospheric DBD plasma | Air | Frequency: 60 kHz, gap: 3 mm, voltage: 20 kV, Power density: 1.14 W/cm2, time: 3–25 s. | [299] |
| 7 | Peptone solution | E. coli, S. aureus, S. enteritidis, B. cereus | Atmospheric pulsed bubble discharge | N2, CO2, Air | Pulse rate: 320 pps, voltage: 28 kV, pulse width: 90 ns, time: 50 s, gas flow: 10 L/min. | [288] |
| 8 | Spinach | F. oxysporum | Atmospheric barrier-type surface discharge plasma | Air, O2, N2, He, Ar | Pulsed plasma directly into the solution. Voltage: 16 kV, pulse width: 20 µs, pulse cycle: 200 µs, gas flow: 500 mL/min, time: 5–50 min. | [293] |
| 9 | Emulsion-type sausage | Plasma-treated water as a nitrate source | Atmospheric surface DBD plasma | Air | Frequency: 15 kHz. | [300] |
| 10 | Raw milk | Lipid composition of milk | Atmospheric AC corona discharge | Air | Time: 3–20 min, gap: 8 mm, current: 90 mA, voltage: 9 kV. | [301] |
| 11 | Pomegranate juice | Anthocyanins and color | Atmospheric plasma jet | Ar | Time: 3, 5, 7 min, juice volume: 3, 4, 5 cm3, gas flow: 0.75, 1, 1.25 L/min, gap: 1.5 cm, frequency: 25 kHz, power: 6 W, voltage: 2.5 kV, current: 3 mA. | [302] |
| 12 | Tomato juice | Volatile components | Atmospheric bubbling discharge | Air | Voltage: 10 kV, time: 5 min. | [303] |
| 13 | Chokeberry juice | Stability of hydroxycinnamic acids, flavonols and anthocyanins | Atmospheric plasma jet | Ar | Frequency: 25 kHz, power: 4 W, gas flow: 0.75 L/min, juice volume: 3, 5, 7 cm3, time: 3, 5 min, gap: 1.5 cm. | [304] |
| 14 | Commercial pasteurized and raw milk | E. coli | Atmospheric nanosecond pulsed bubble discharge | Ar | A gas bubble discharge was generated inside milk using a needle to plate electrode configuration, immersed in milk. Frequency: 2.5, 4 kHz, time: 75–120 s, gap: 1 cm, pulse width: 10 ns, voltage: 9 kV. | [305] |
| 15 | Sour cherry juice | Content of anthocyanins and phenolic acids | Atmospheric plasma jet | Ar | Frequency: 25 kHz, power: 4 W, gas flow: 0.75, 1, 1.25 L/min, juice volume: 2, 3, 4 mL, time: 3, 4, 5 min, gap: 1.5 cm, voltage: 2.5 kV, current: 3 mA. | [306] |
| No | Type of Oil | Electrode Geometry | Streamer Polarity | Gap (cm) | Description | Reference |
|---|---|---|---|---|---|---|
| 1 | Commercial mineral transformer oil | Point-plane | Negative | 0.5–35 | Grounded plane in the oil. Voltage: 460 kV. | [328] |
| 2 | Mineral oil | Point-plane | Positive | 2.5–30 | Under impulse voltage. System bandwidth ~35 MHz, voltage: 500 kV, impulses: 0.4/1400 µs. | [321] |
| 3 | Transformer oil | Point-plane | Negative, positive | 0.3 | Pulse duration: 0–10 µs, voltage: 50, 70 kV. | [319] |
| 4 | Pharmaceutical grade white oil | Point-plane | Negative, positive | 8 | Bush-like filamentary streamers. Voltage: 0–500 kV. | [334] |
| 5 | Mineral oil | Point-plane | Positive | 5–10 | High voltage Impulses: 0.4/1400 µs, voltage: 102, 138, 184 kV. | [341] |
| 6 | Cyclohexane with pyrene additive | Point-plane | Positive | 0.6, 5 | Voltage: 4–450 kV, high voltage Impulses: 0.4/1400 µs. | [331] |
| 7 | Silicone oil, transformer oil | Point-plane | Positive | 0.2–0.3 | Voltage: 24 kV. | [314] |
| 8 | Mineral oil | Point-plane | Positive | 2–10 | Voltage: 104–352 kV. | [326] |
| 9 | Insulating oil | Point-point, point-plane | Negative, positive | Point-point: 15–30, 45–60 Point-plane: 15–45, 60–100 | Frequency of applied voltage: 50 Hz, lightning impulse voltage duration: 1/40 µs, switching impulse voltage duration: 600/3600 µs. | [342] |
| 10 | Transformer oi | Sphere-plane | Negative, positive | 30, 60 | AC voltage: 800 kV, duration of the discharge: 50–100 ns. | [343] |
| 11 | Insulating oil | Point-plane | Negative, positive | 1–7 | Strong non-uniform field at voltages up to 700 kV. | [323] |
| 12 | Transformer oil | Point-plane | Positive | 5–20 | Under step and AC voltages. Positive impulse: 1.2/700 µs, voltage: 500 kV. | [324] |
| 13 | Oil | Point-plane | Negative, positive | 7.62 | Impulsive 1.5/40 µs wave. Crest voltage for positive streamer: 190 kV, for negative streamer: 240 kV. | [318] |
| 14 | Silicon oil | – | – | – | 60 MHz (HF)/2 MHz (LF) dual frequency capacitively coupled plasma. Power: 165 W and 100 W, base pressure: 0.5 mPa, work pressure: 50 Pa, discharge gas: C2F6 and CHF3, gas flow: 30 sccm, time: 30 min. | [344] |
| 14 | Mineral oil | Point-plane | Negative, positive | 10, 20, 35 | Under impulse voltage. Positive impulse: 1.2/1400 µs, voltage: 470 kV | [327] |
| 15 | Synthetic and natural ester transformer liquids | Point-plane | Negative, positive | 1.5–10 | Standard lightening impulse duration: 1.2/50 µs, voltage: 60, 80, 110, 230, −70, −110, −210, −290, −320 kV. | [336] |
| 16 | Mineral oil | point-plane, sphere-plane | Negative, positive | 10, 30, 60, 80 | AC voltage: 325, 625 kV. | [325] |
| 17 | Natural ester liquid | Point-plane | Negative, positive | 2–20 | Voltage up to 460 kV, impulse: 0.5/1400 µs. | [335] |
| 18 | Commercial naphthenic transformer oil | Point-plane | Negative, positive | 6.7 | Voltage for positive point: 188, 165 kV, for negative point: 300 kV, impulse: 1/180 µs. | [320] |
| 19 | Brazilian heavy crude oil containing emulsified water | – | – | 2 | DBD plasma using different gases: CO2, H2 and natural gas. Time: 1, 1.5, 4 h, voltage: 13 kV. | [340] |
| 20 | Heavy oil and cokes from petrochemical refinery processes | – | – | 5 | 2.45 GHz microwave cold water plasma. Time: 30 min, power: 80 W. | [337] |
| 21 | Heavy oil | Packed-bed, plate-plate | – | Packed-bed: 5–25 Plate-plate: 0.3–1 | Packed-bed reactor: 60 Hz AC voltage for Ar spark discharge, gas flow: 50–400 mL/min, power: 5–25 W. Plate-plate reactor: 50/60 Hz AC current, voltage: 9 kV, Ar gas flow: 50–400 mL/min, power: 3–12 W. | [338] |
| 22 | Heavy oil | Plate-plate | – | 0.3–1 | 60 Hz AC voltage 9 kV, Ar flow rate: 225 mL/min, power: 3–12 W. | [339] |
© 2019 by the authors. Licensee MDPI, Basel, Switzerland. This article is an open access article distributed under the terms and conditions of the Creative Commons Attribution (CC BY) license (http://creativecommons.org/licenses/by/4.0/).
Share and Cite
Rezaei, F.; Vanraes, P.; Nikiforov, A.; Morent, R.; De Geyter, N. Applications of Plasma-Liquid Systems: A Review. Materials 2019, 12, 2751. https://doi.org/10.3390/ma12172751
Rezaei F, Vanraes P, Nikiforov A, Morent R, De Geyter N. Applications of Plasma-Liquid Systems: A Review. Materials. 2019; 12(17):2751. https://doi.org/10.3390/ma12172751
Chicago/Turabian StyleRezaei, Fatemeh, Patrick Vanraes, Anton Nikiforov, Rino Morent, and Nathalie De Geyter. 2019. "Applications of Plasma-Liquid Systems: A Review" Materials 12, no. 17: 2751. https://doi.org/10.3390/ma12172751
APA StyleRezaei, F., Vanraes, P., Nikiforov, A., Morent, R., & De Geyter, N. (2019). Applications of Plasma-Liquid Systems: A Review. Materials, 12(17), 2751. https://doi.org/10.3390/ma12172751

